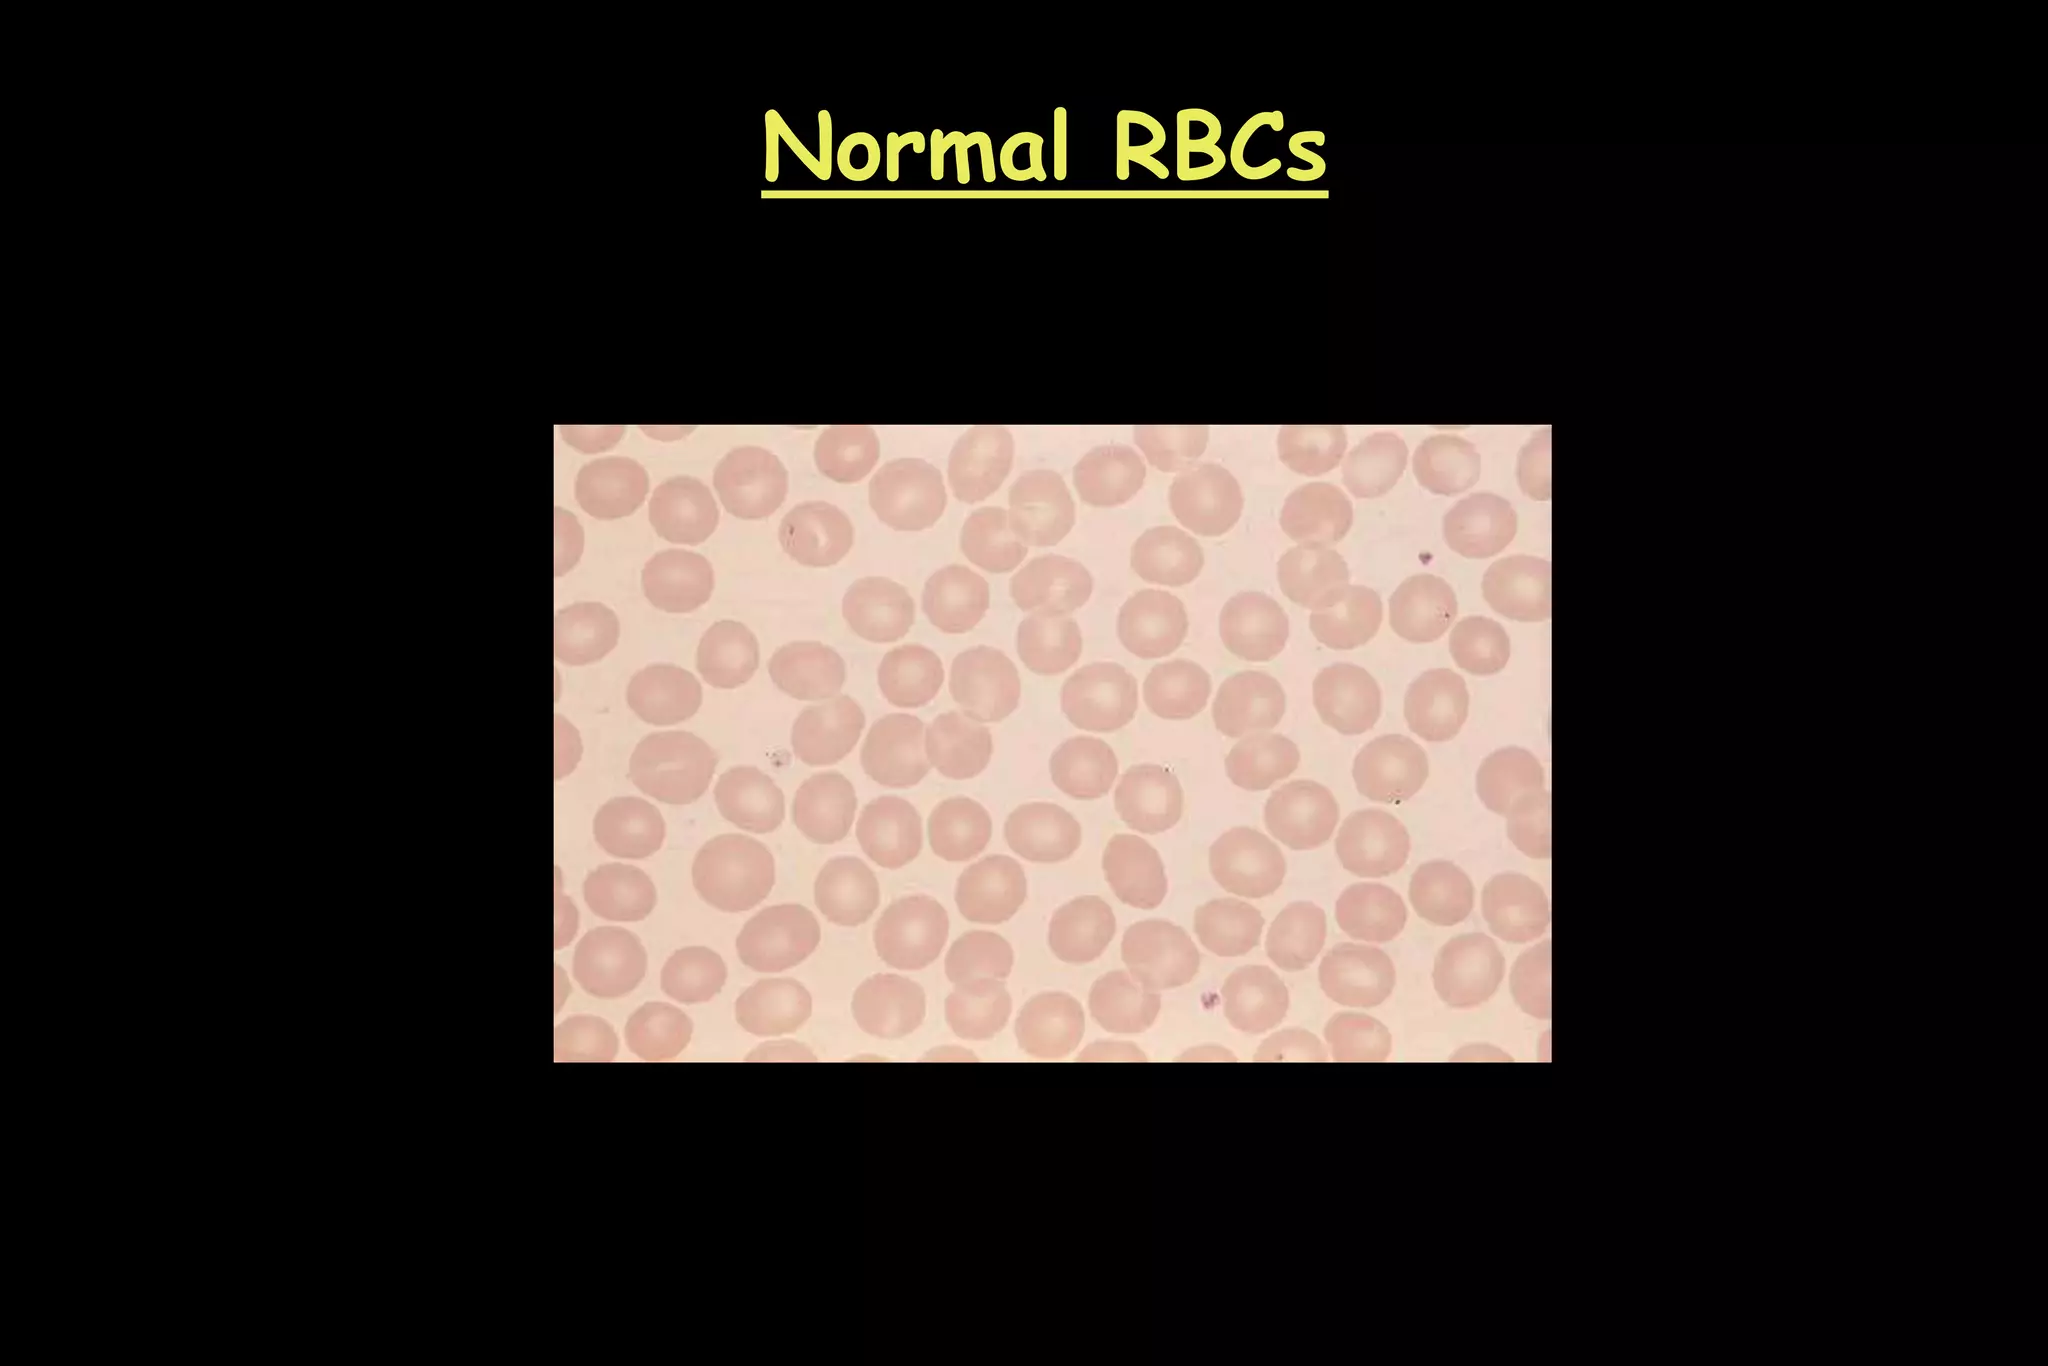
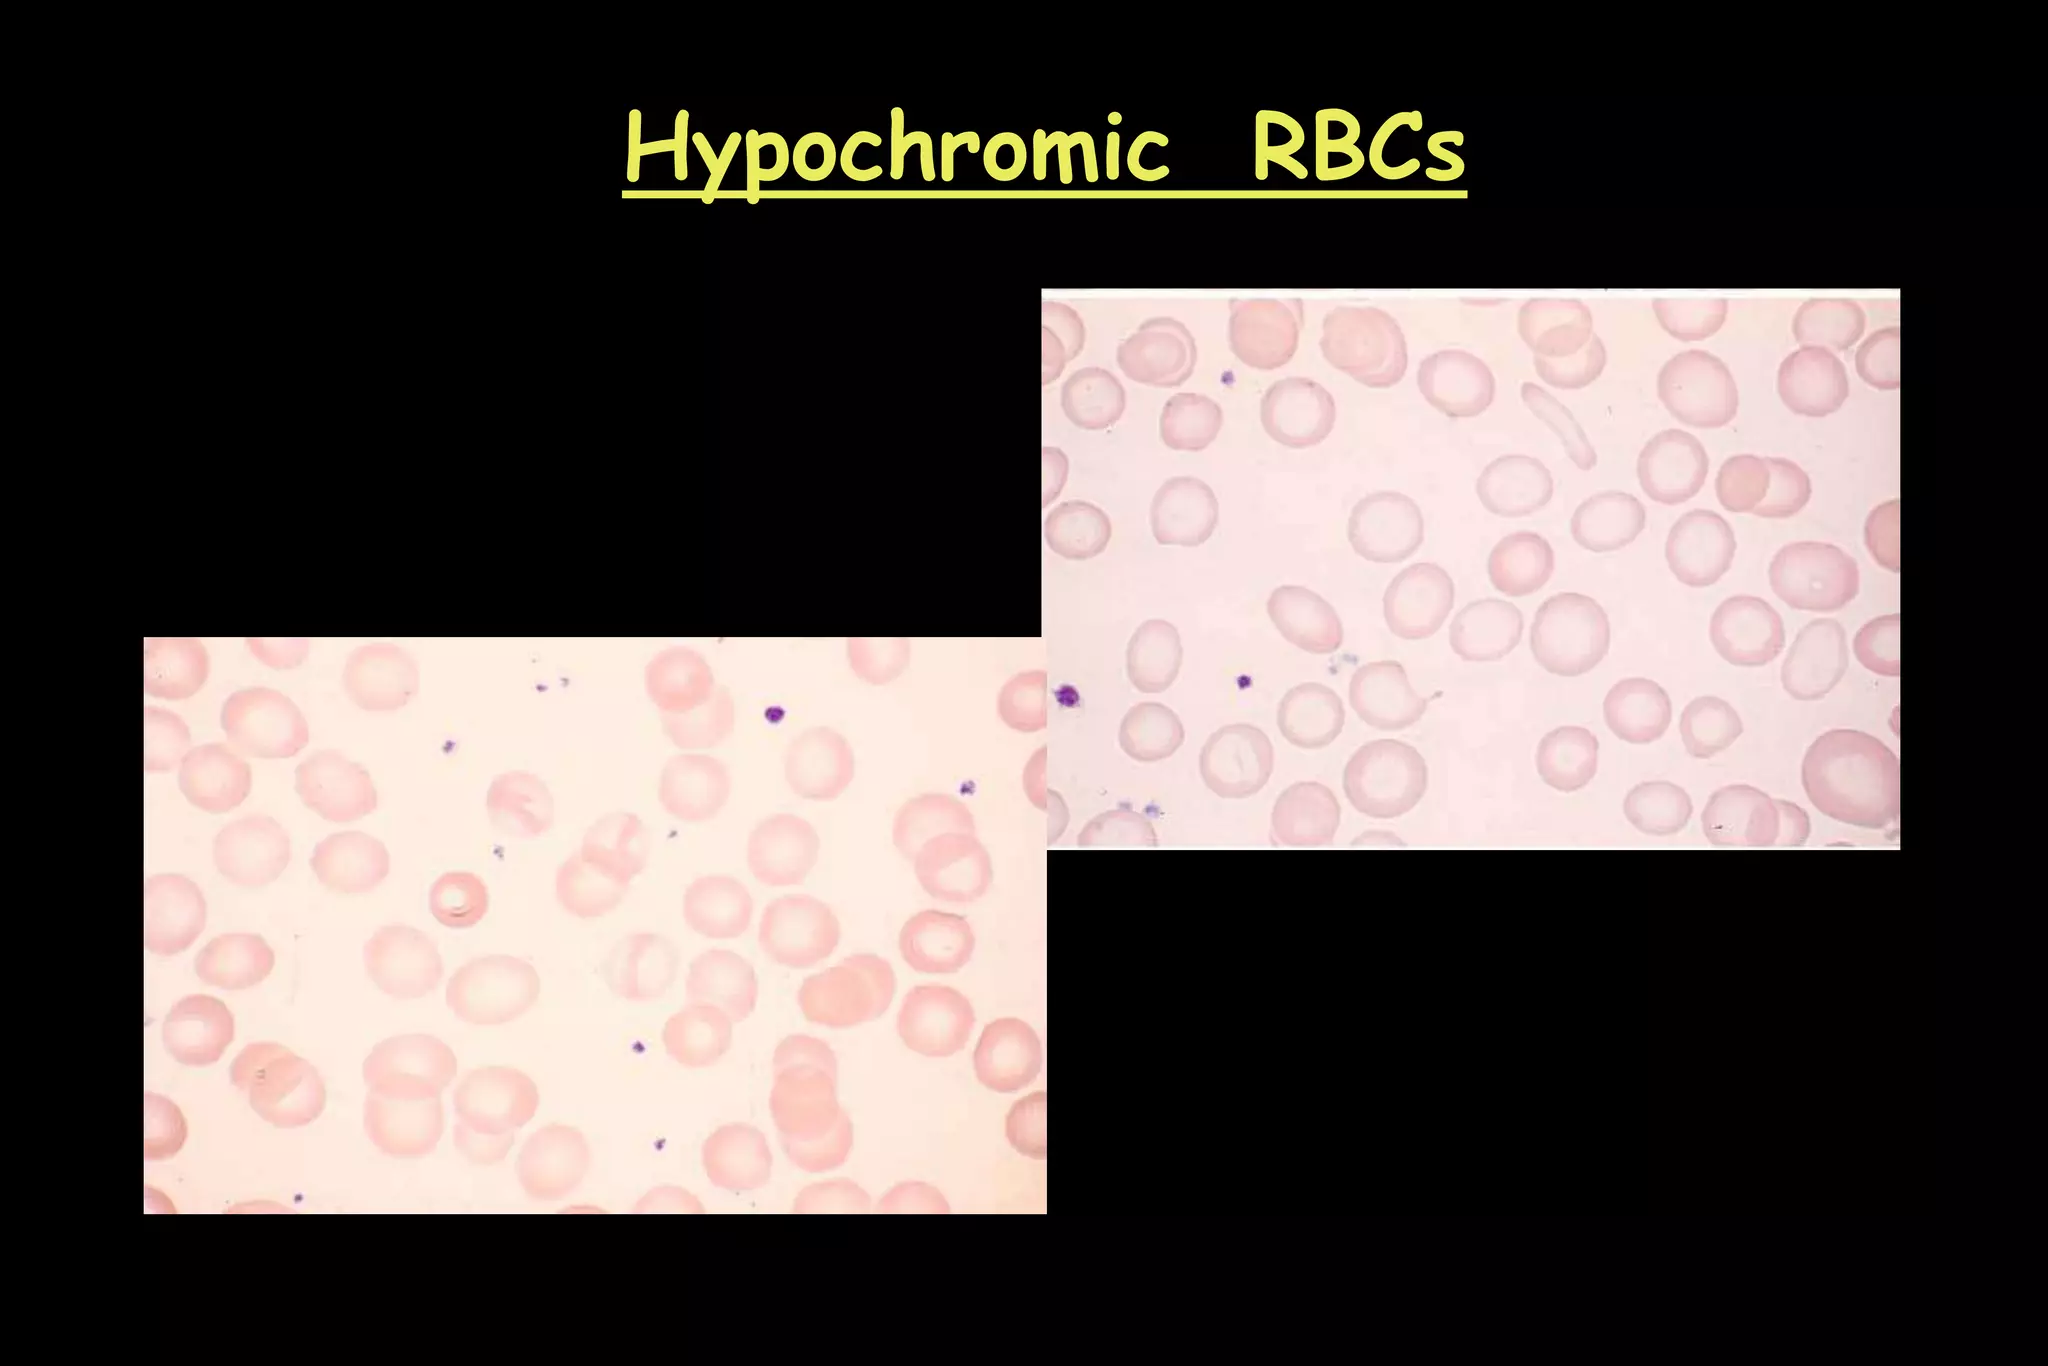
Hypochromic RBCs
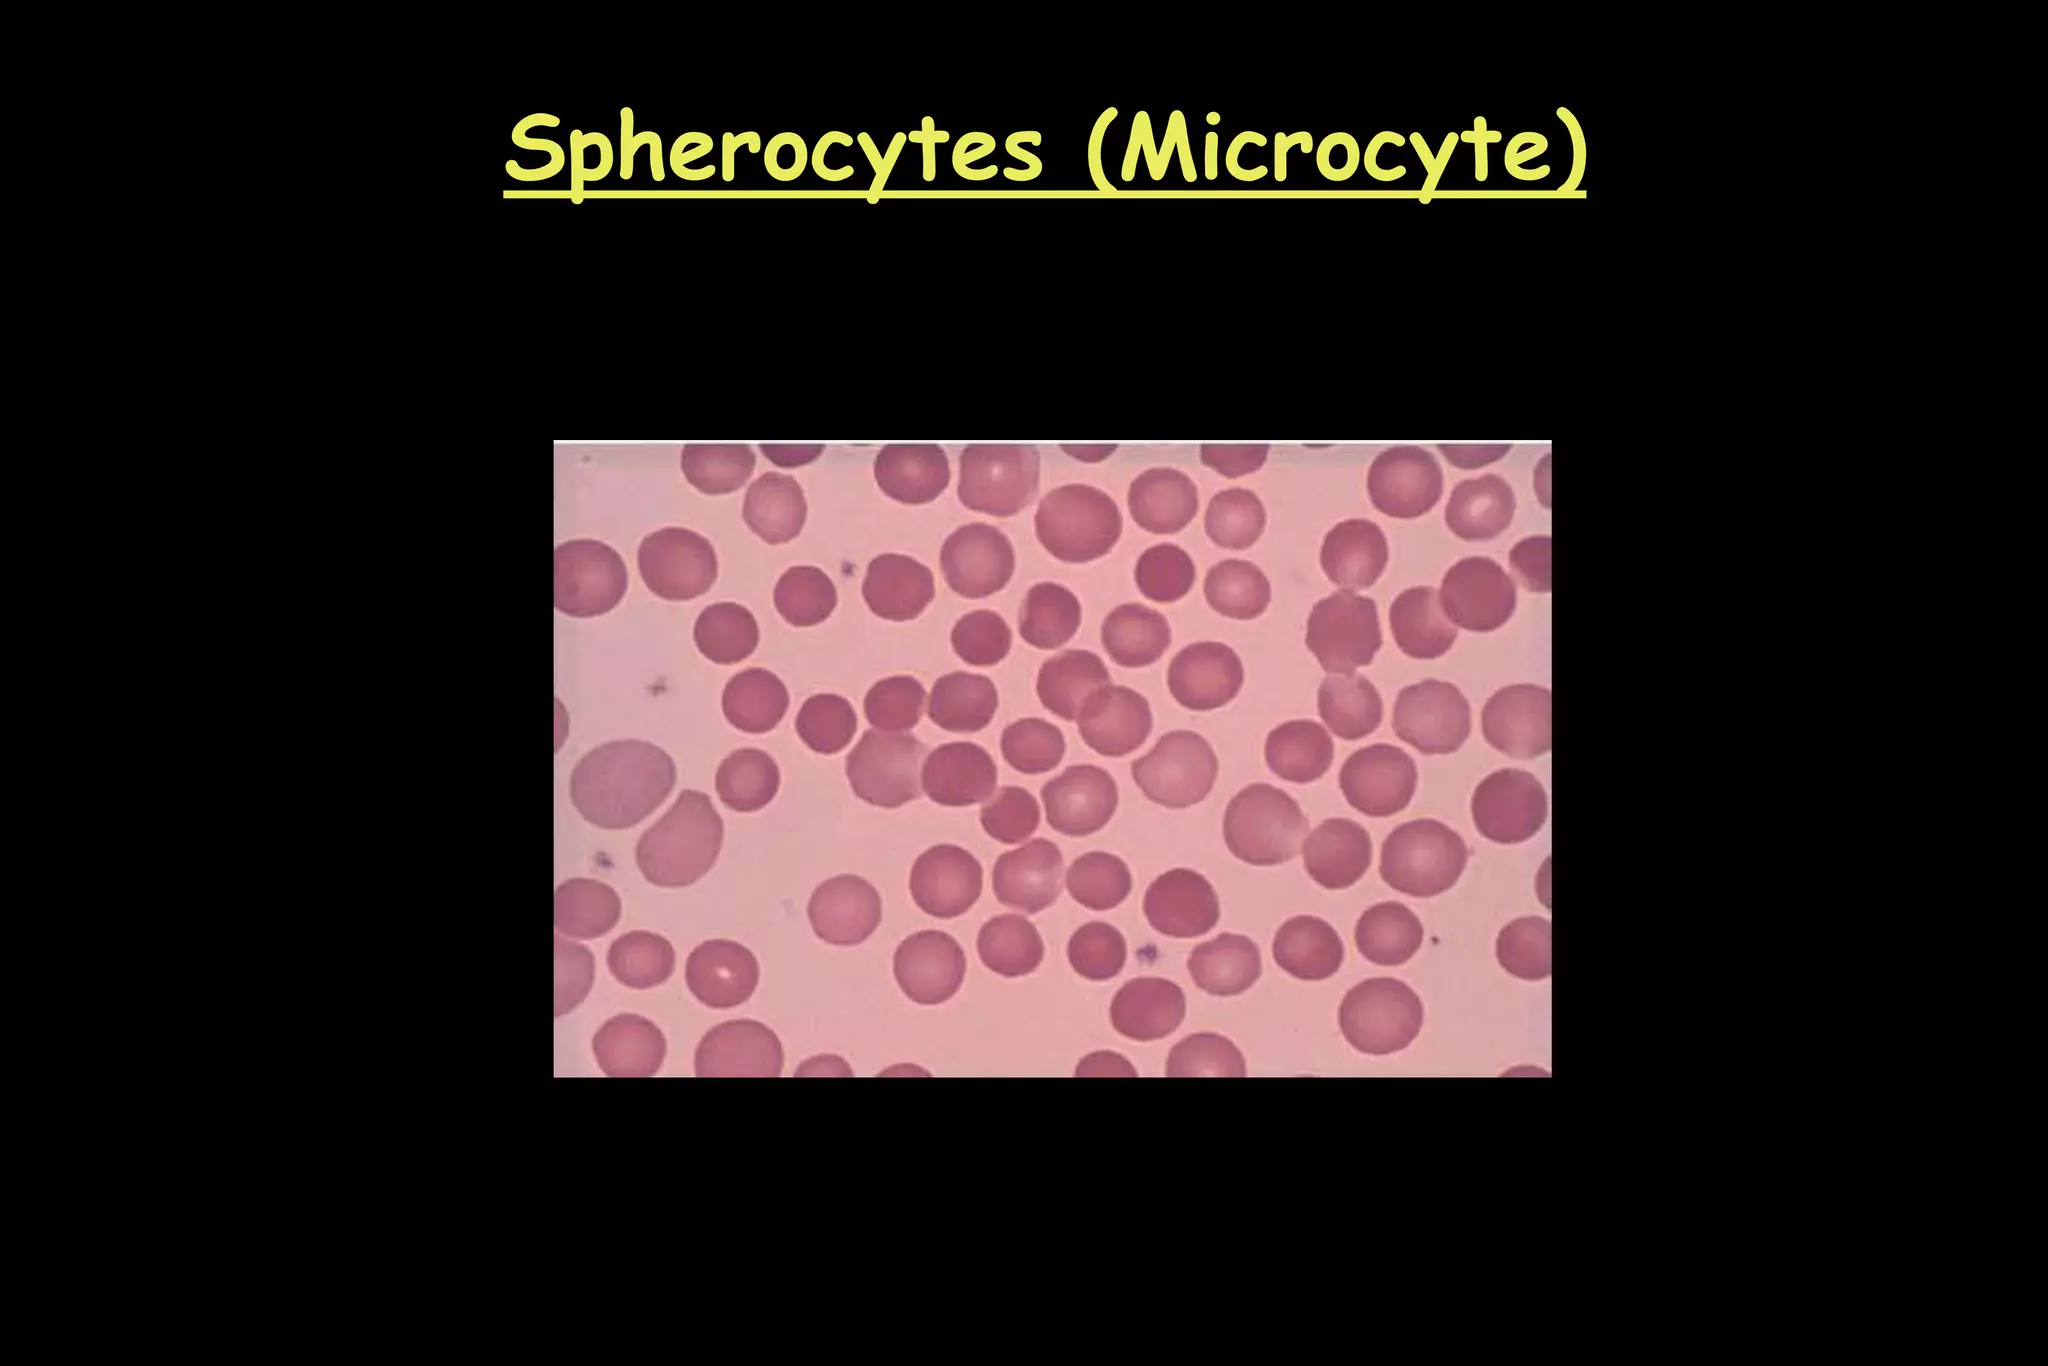
Spherocytes (Microcyte)
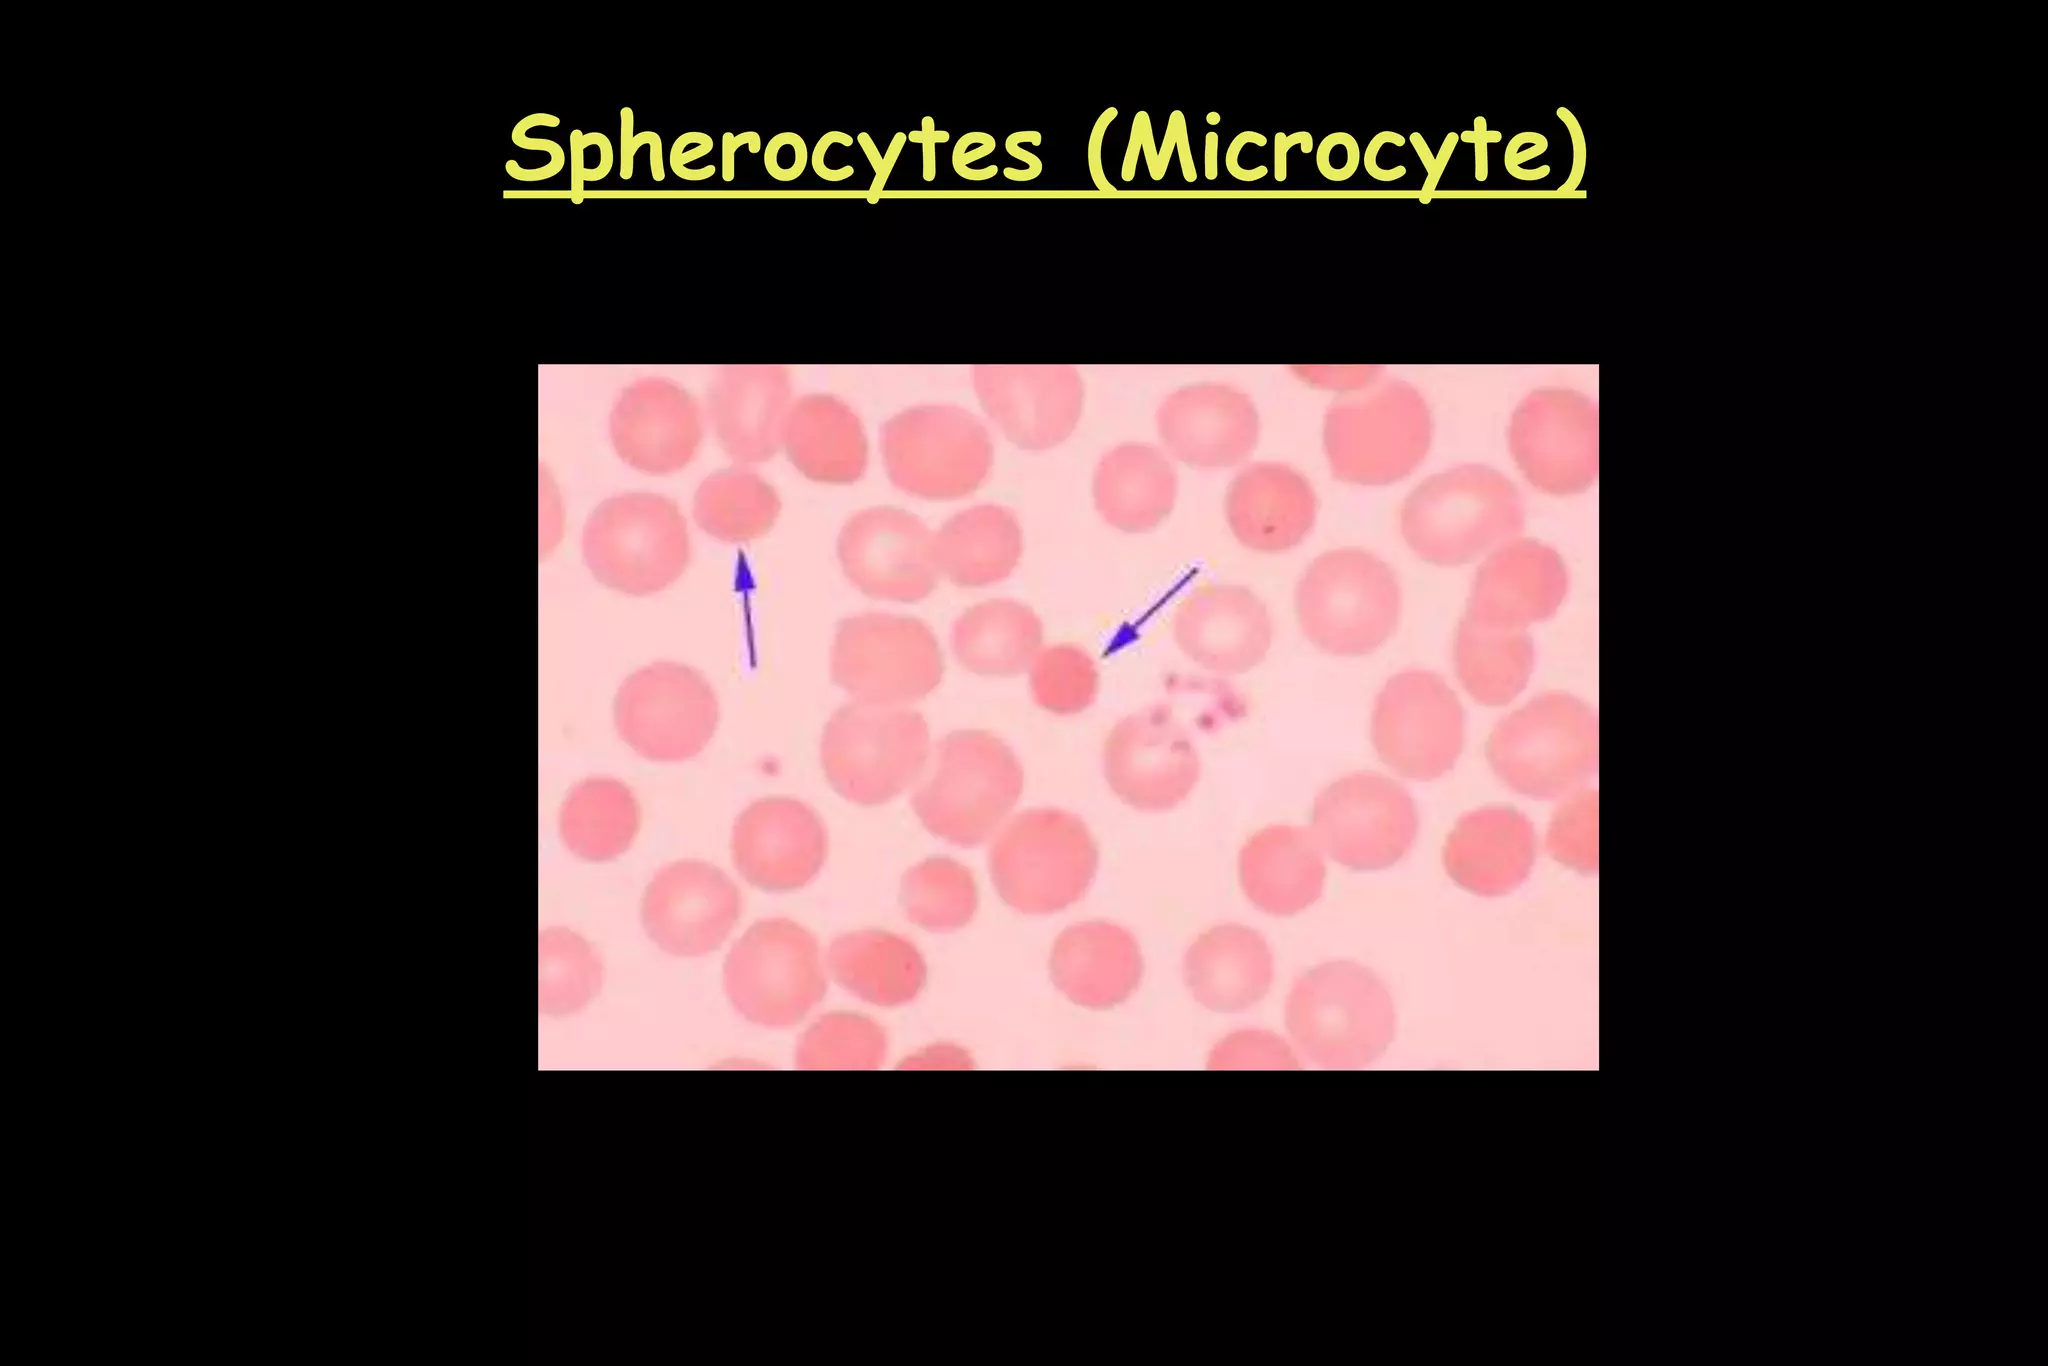
Spherocytes (Microcyte)
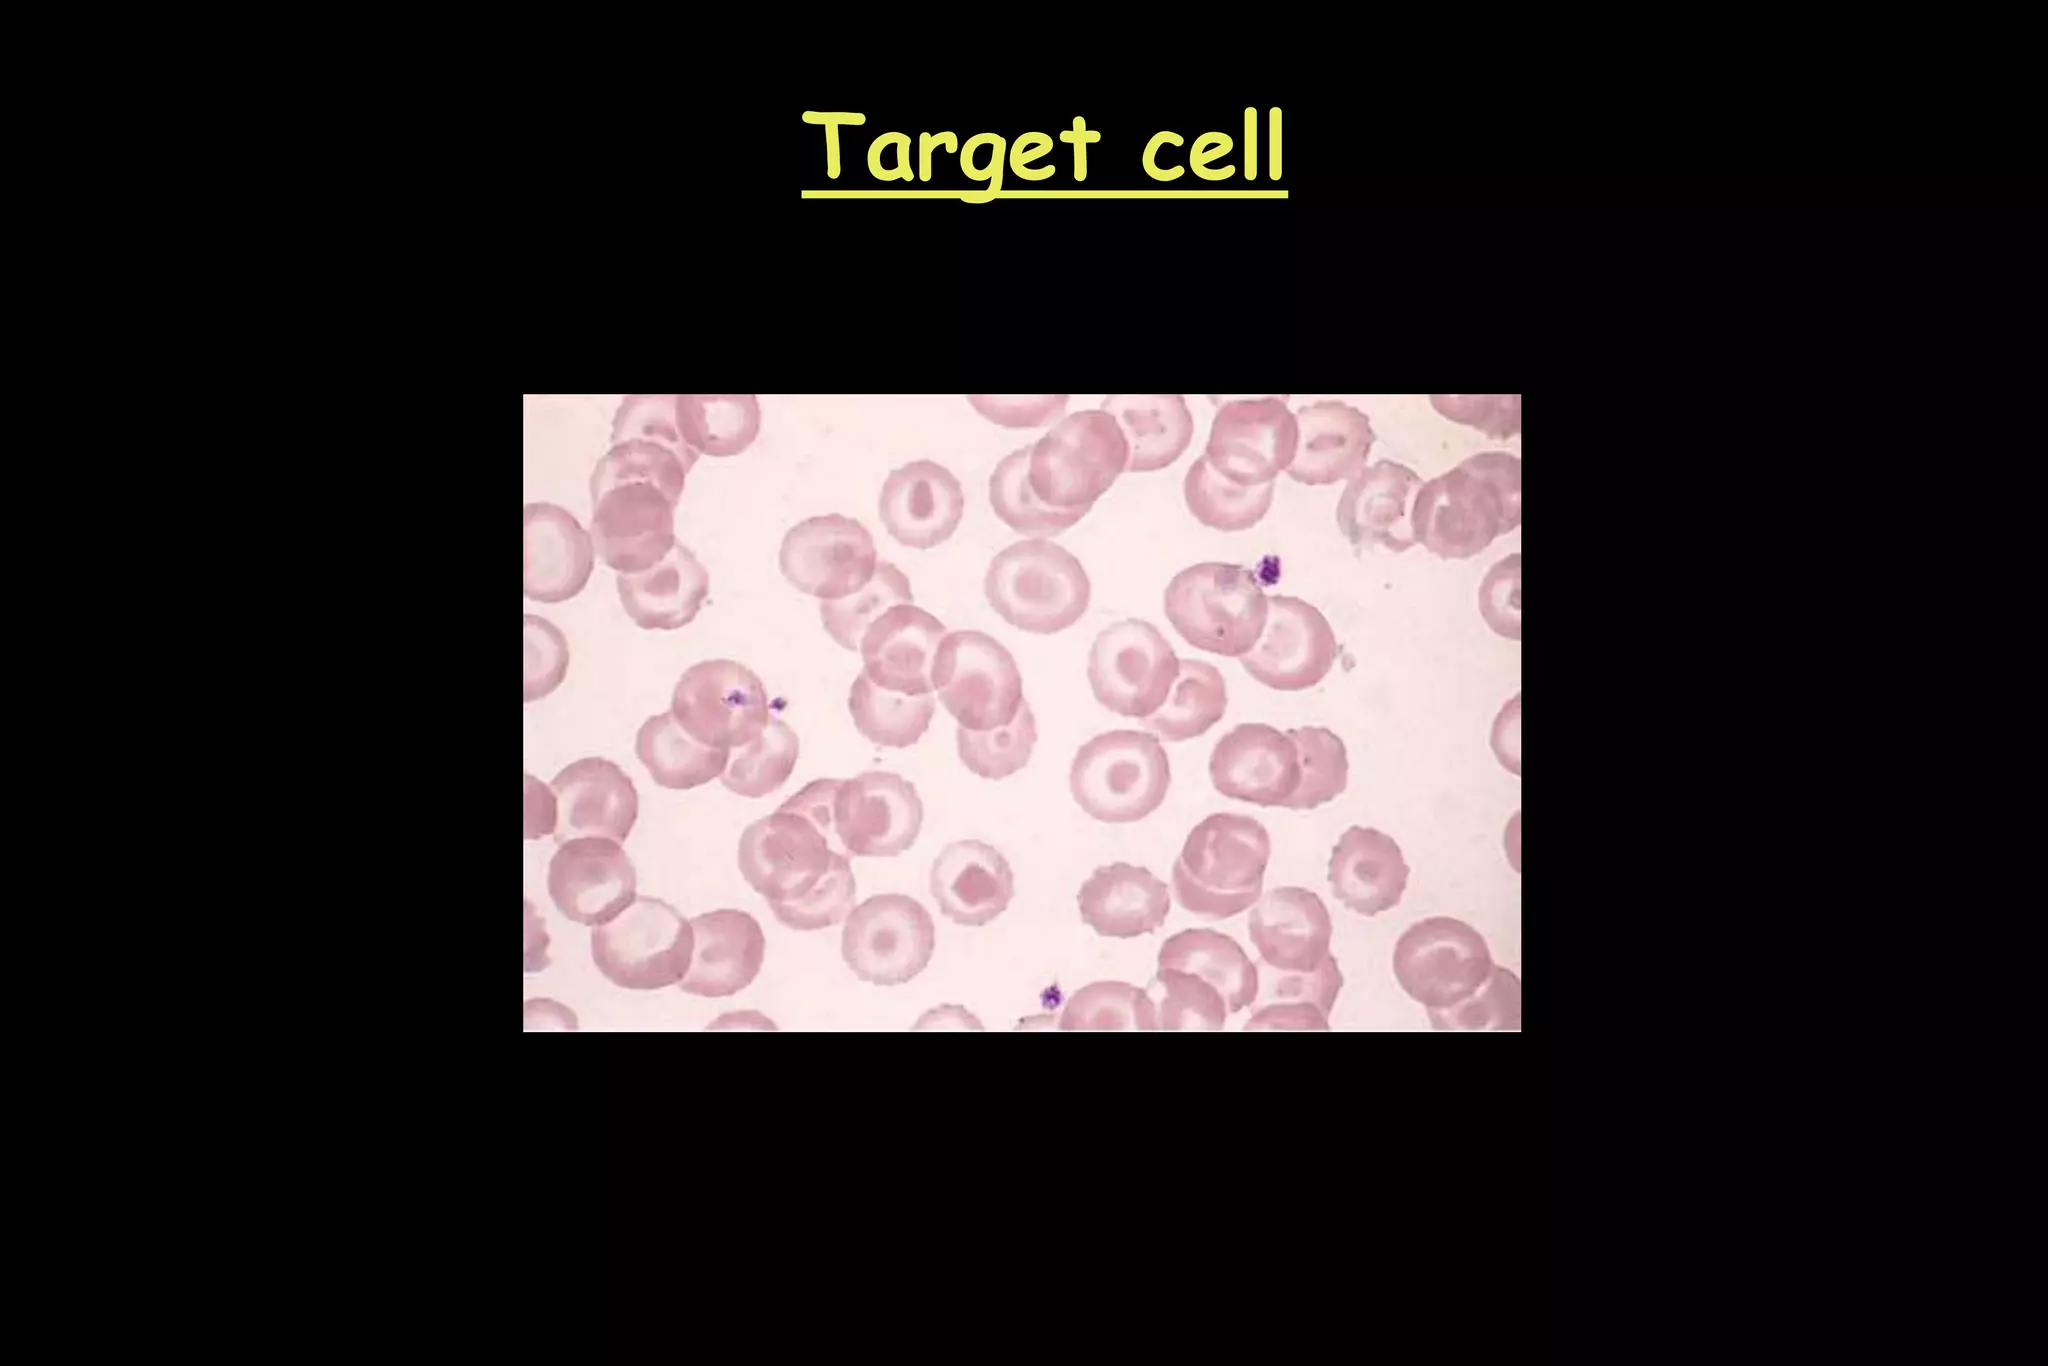
Target cell
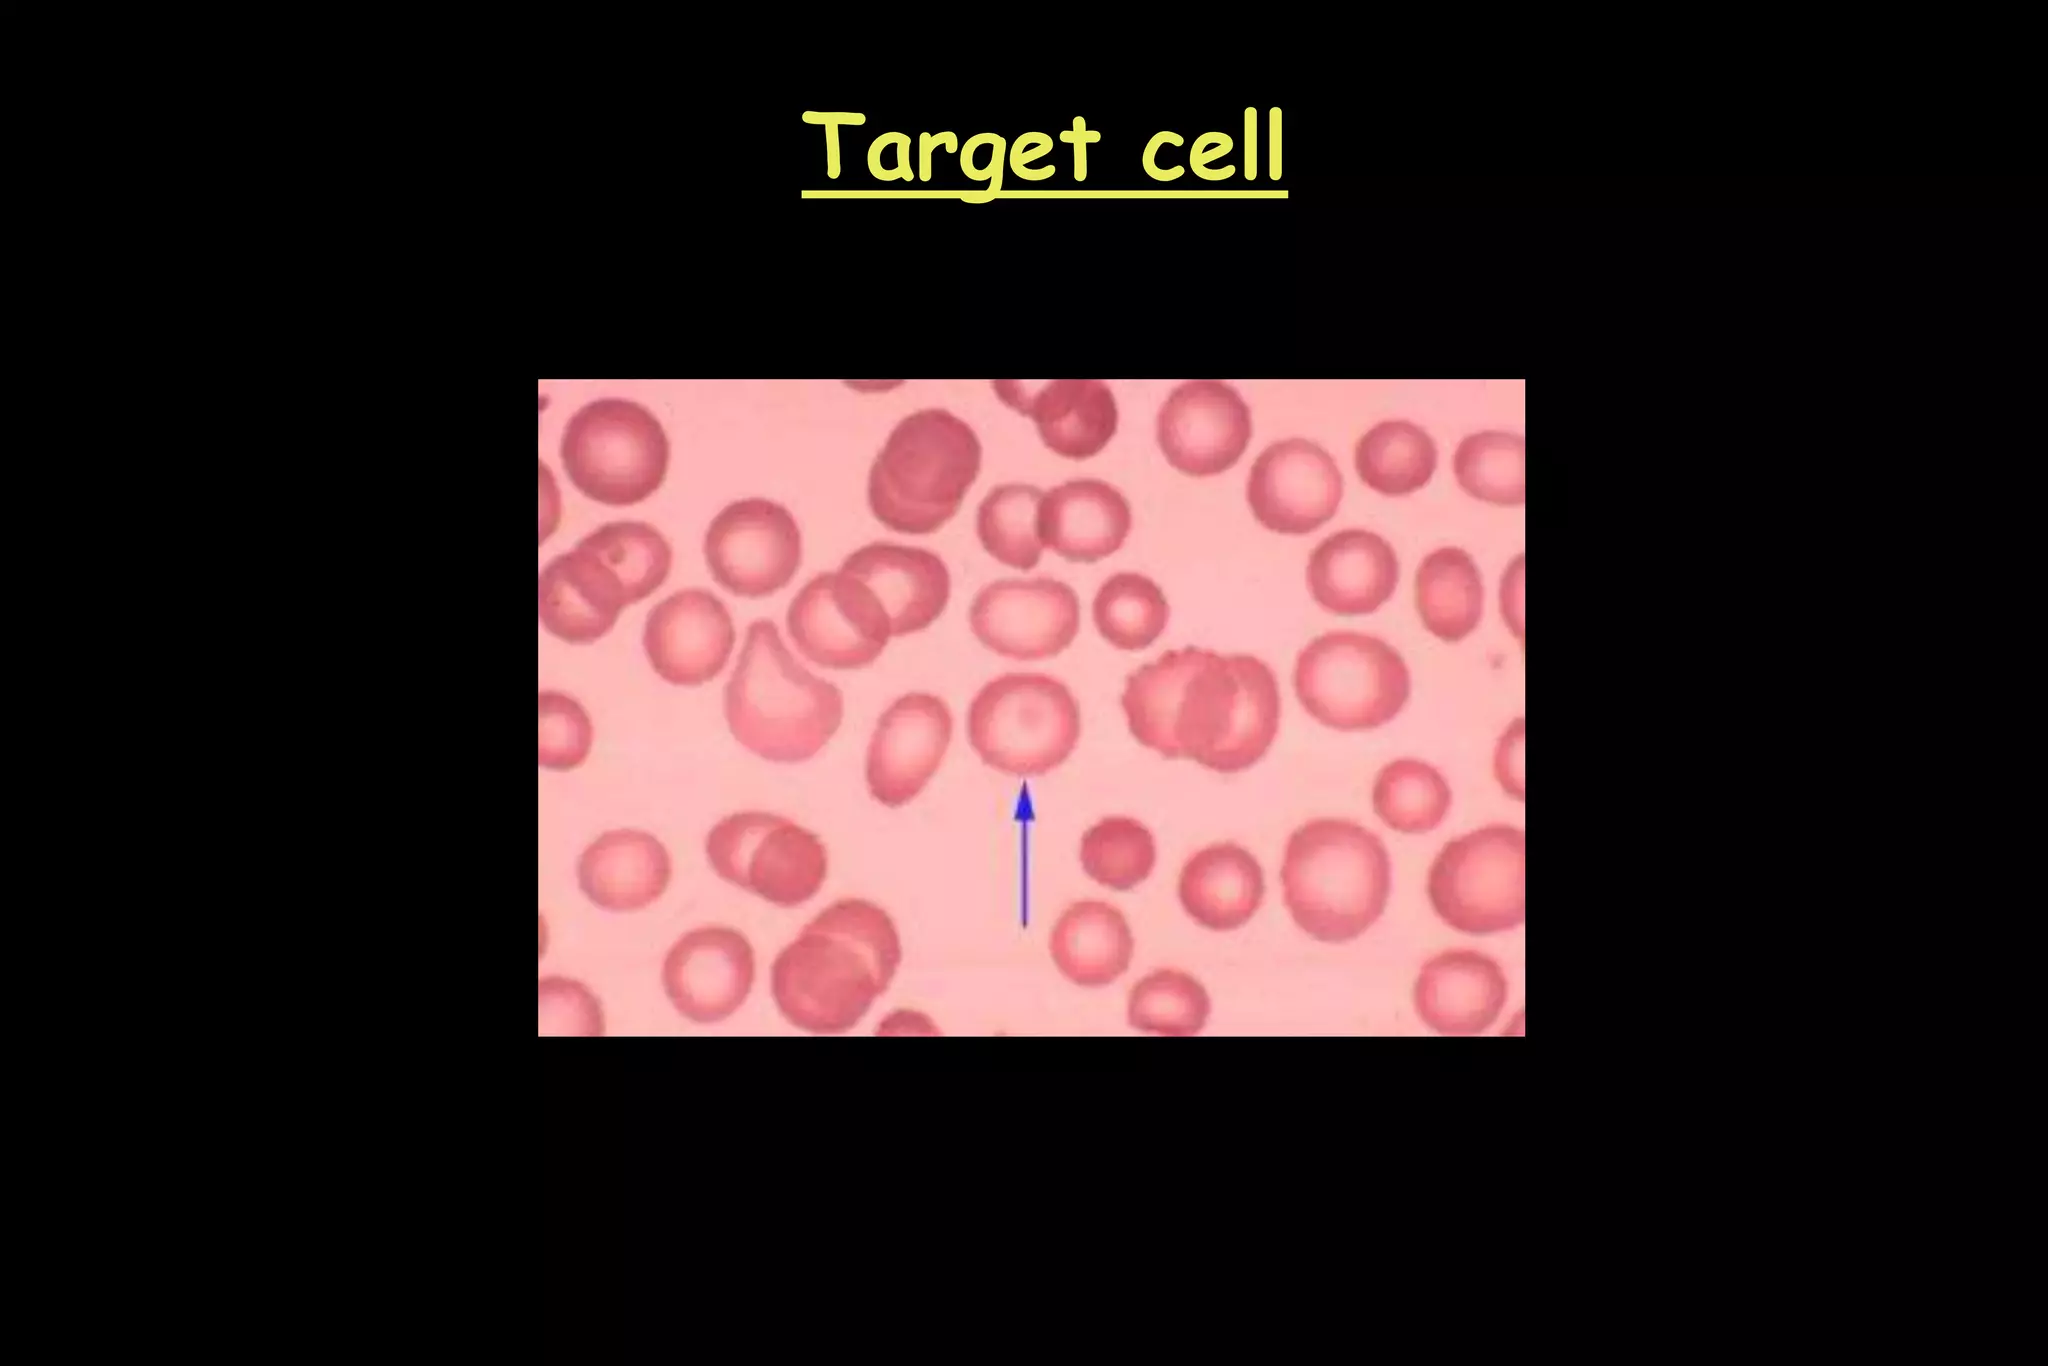
Target cell
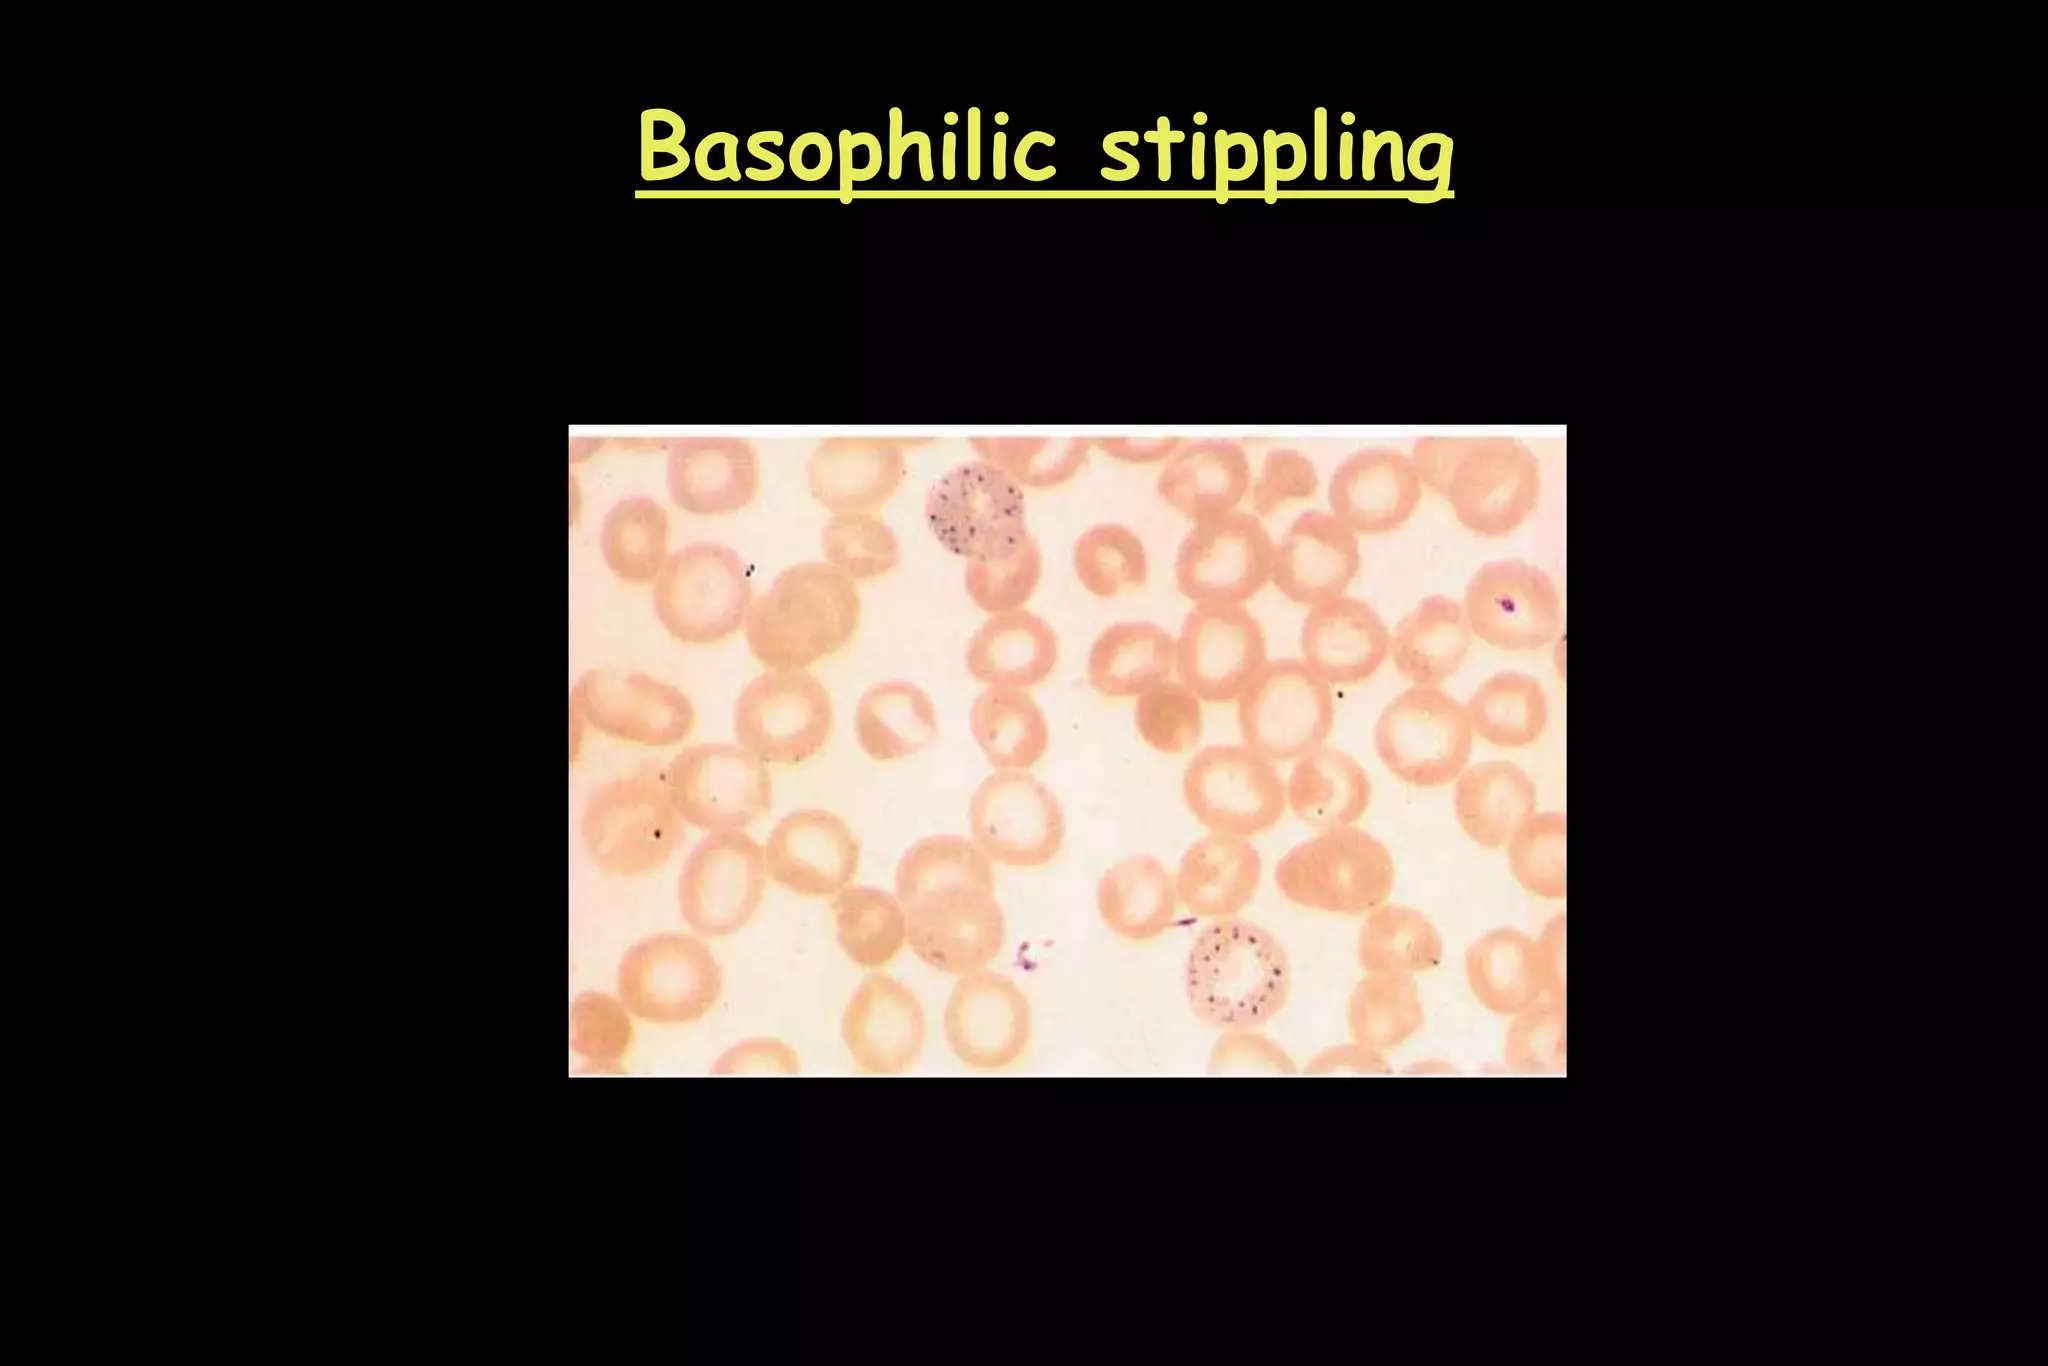
Basophilic stippling
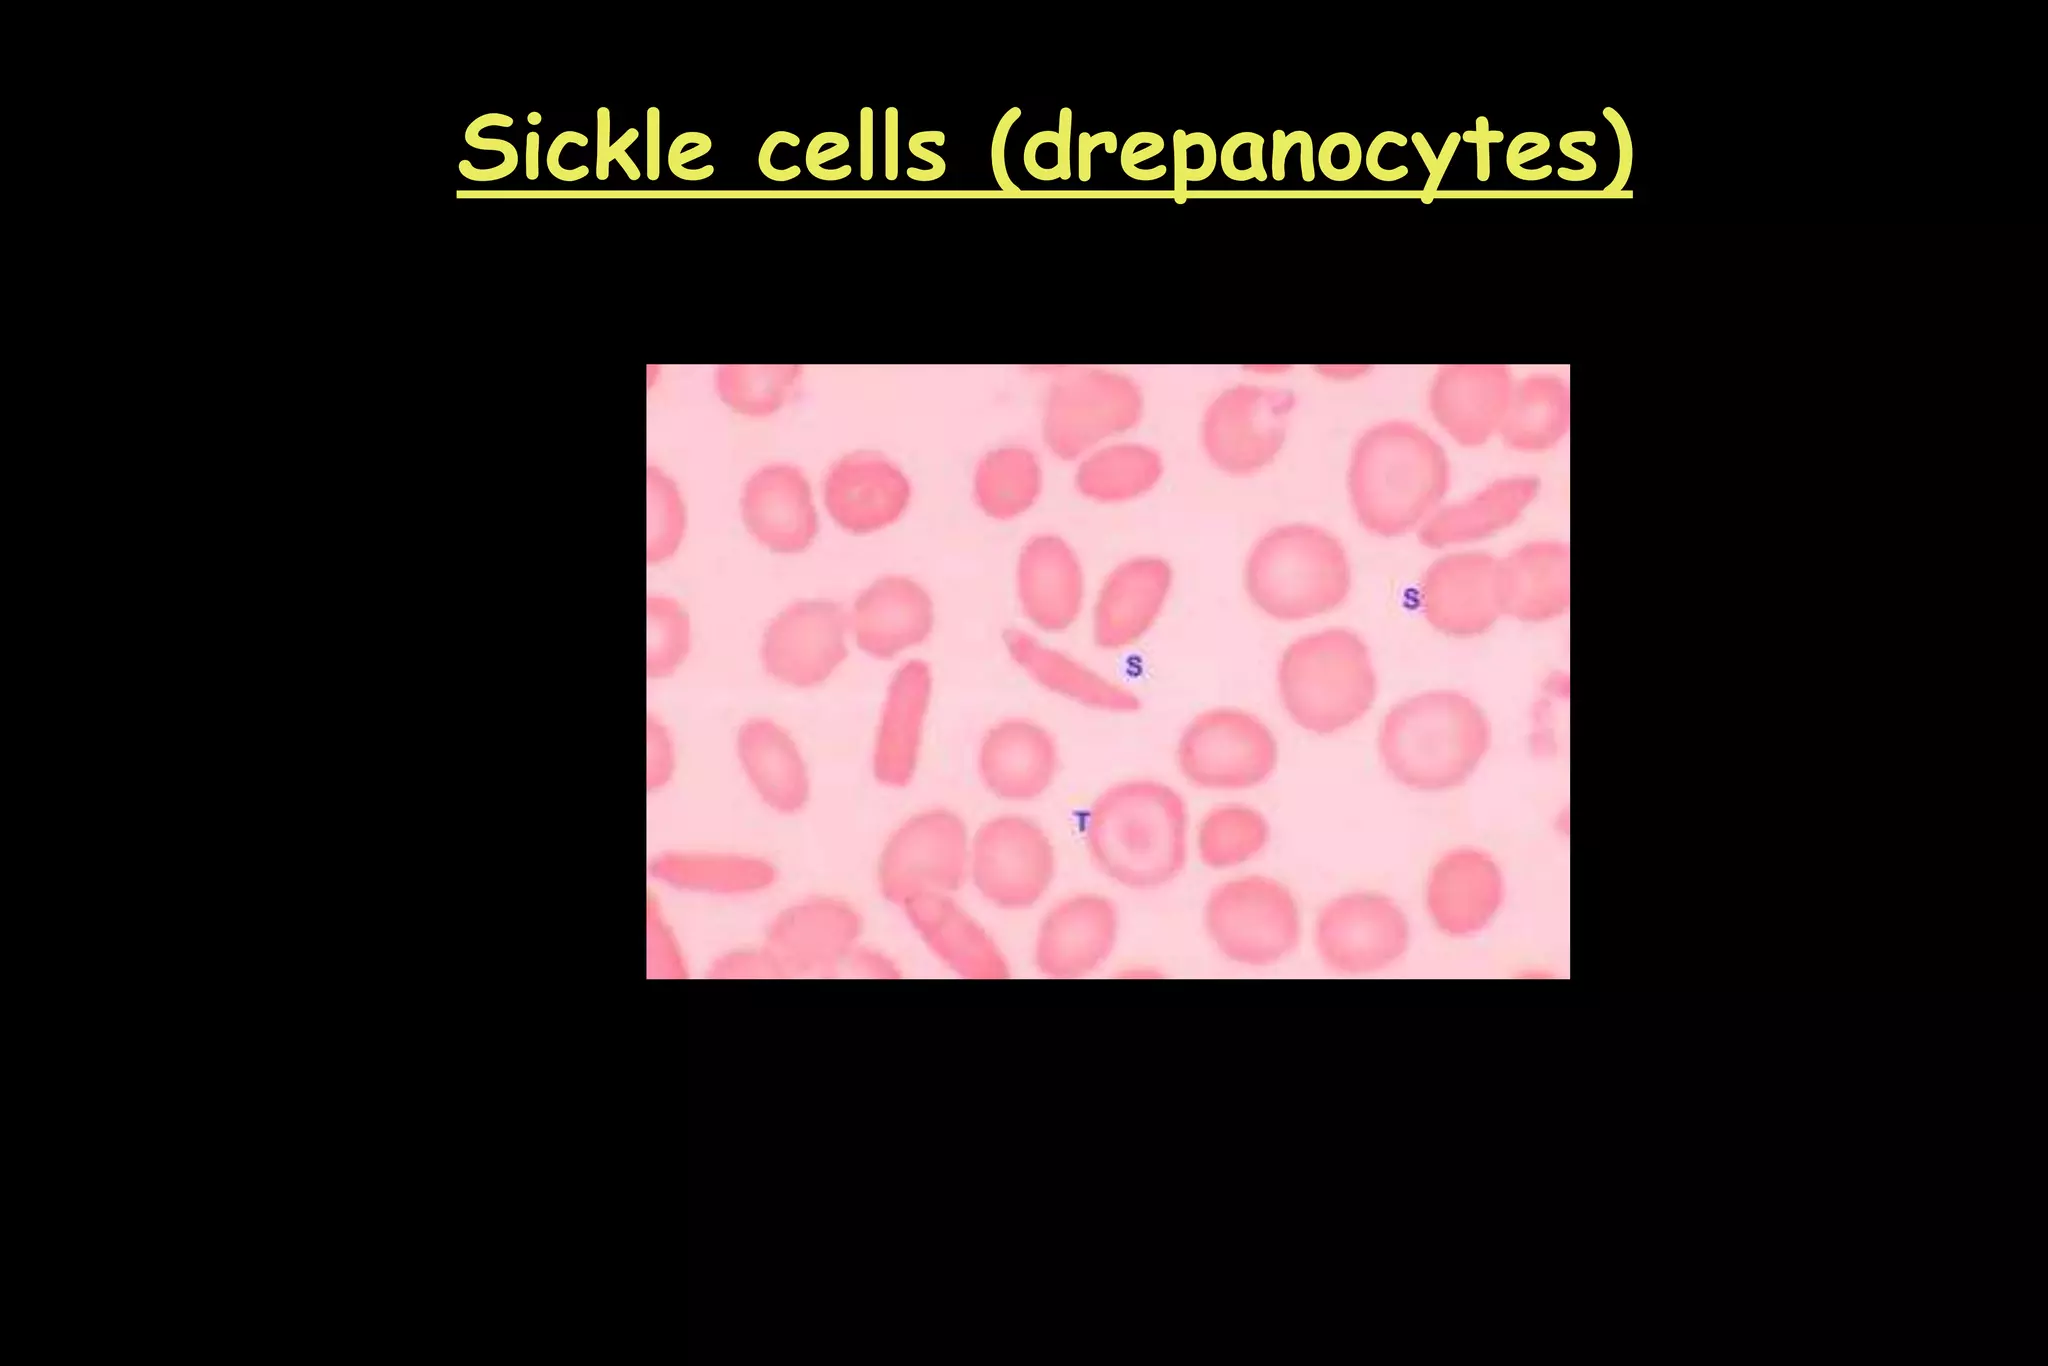
Sickle cells (drepanocytes)
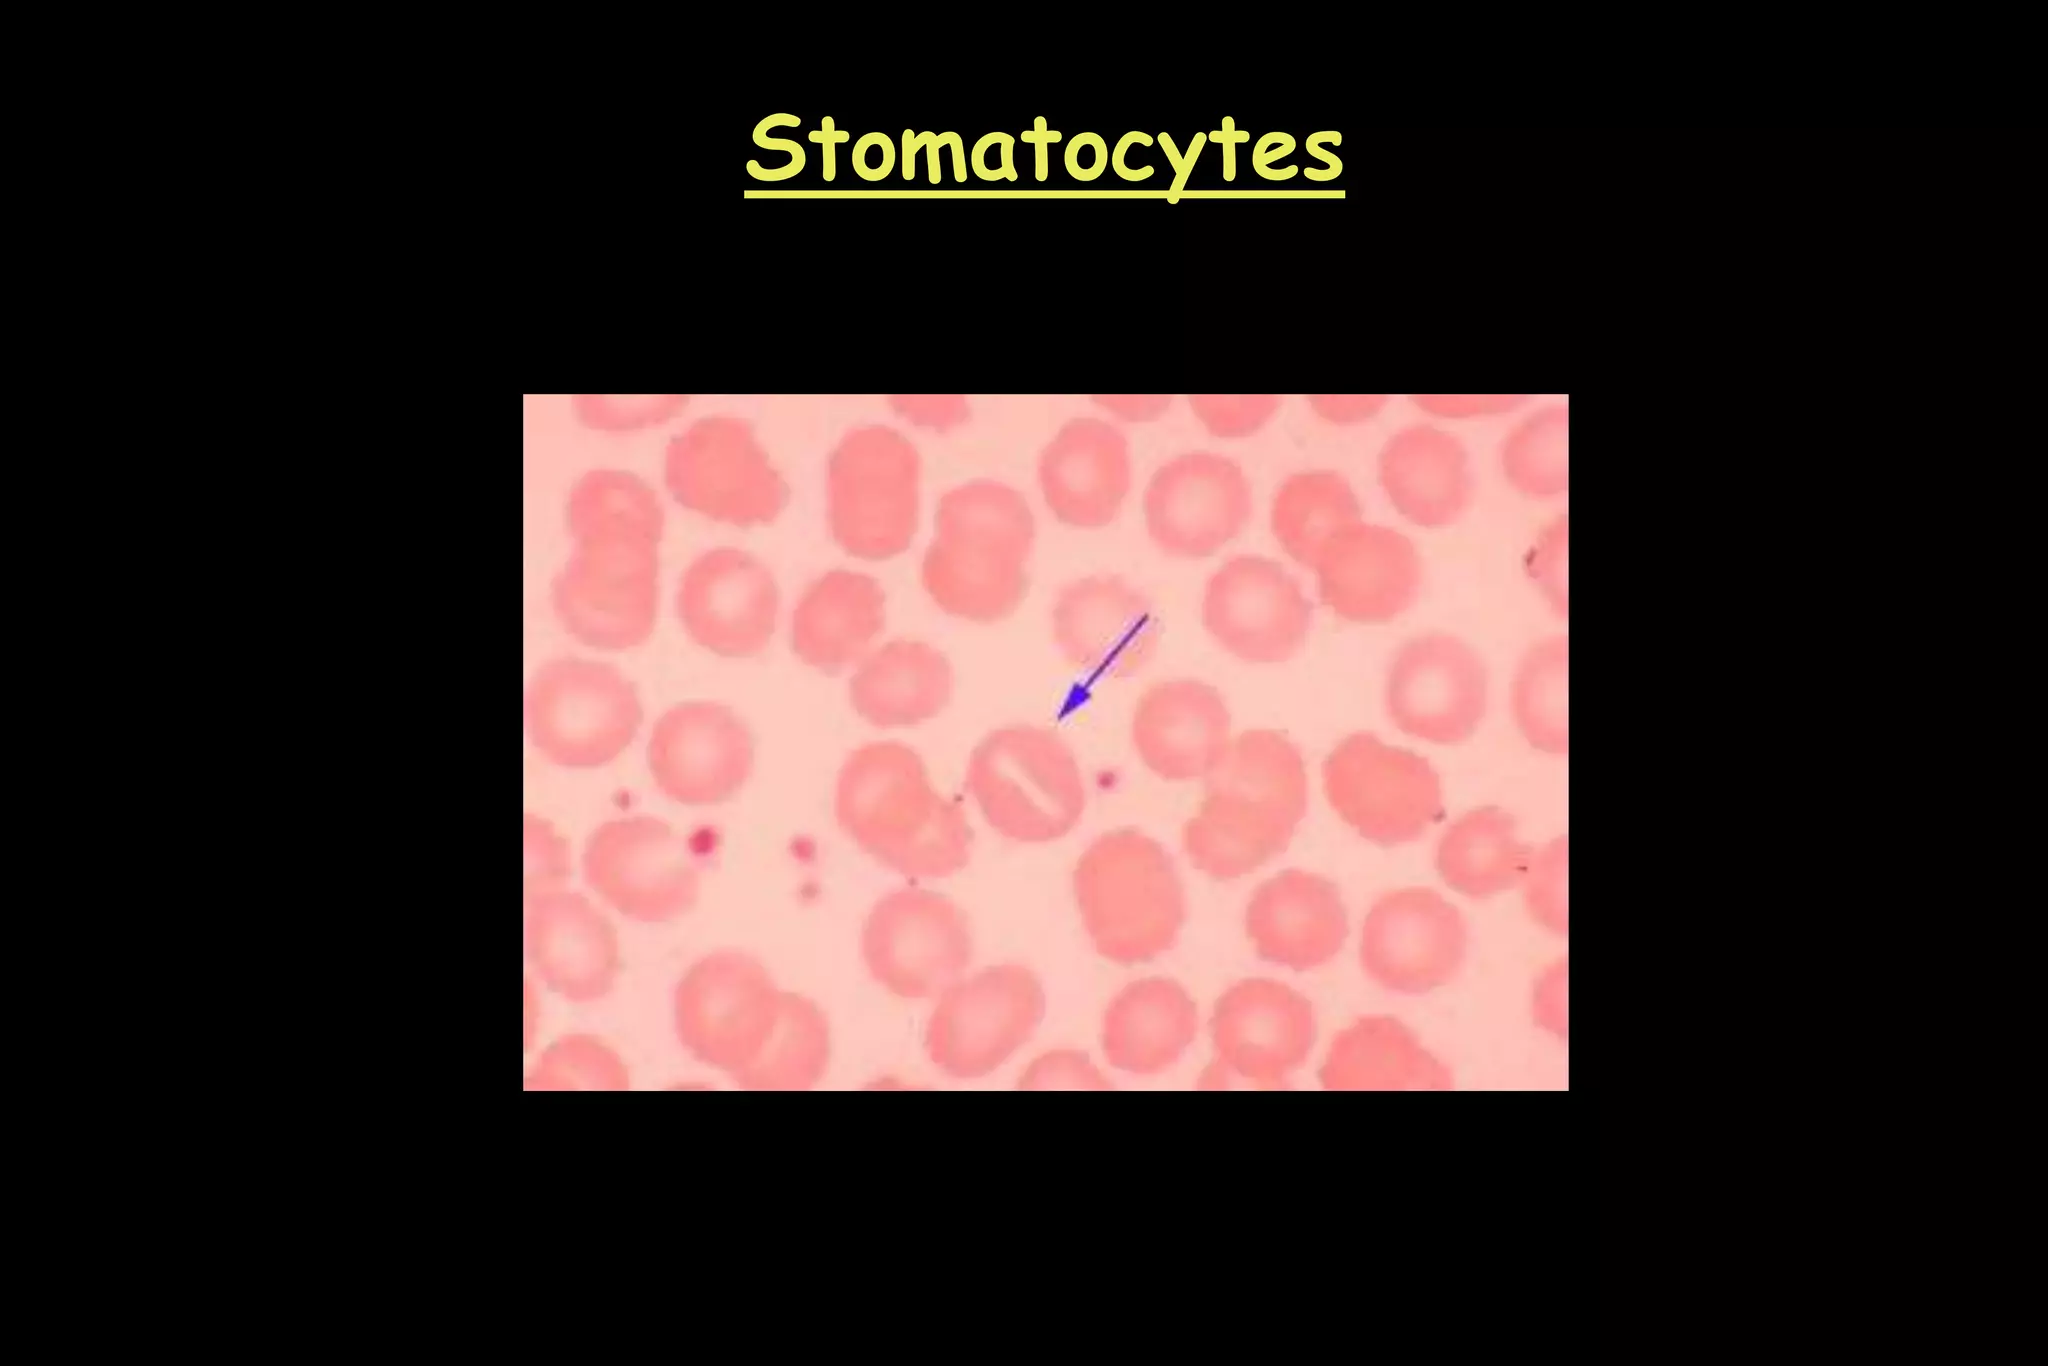
Stomatocytes
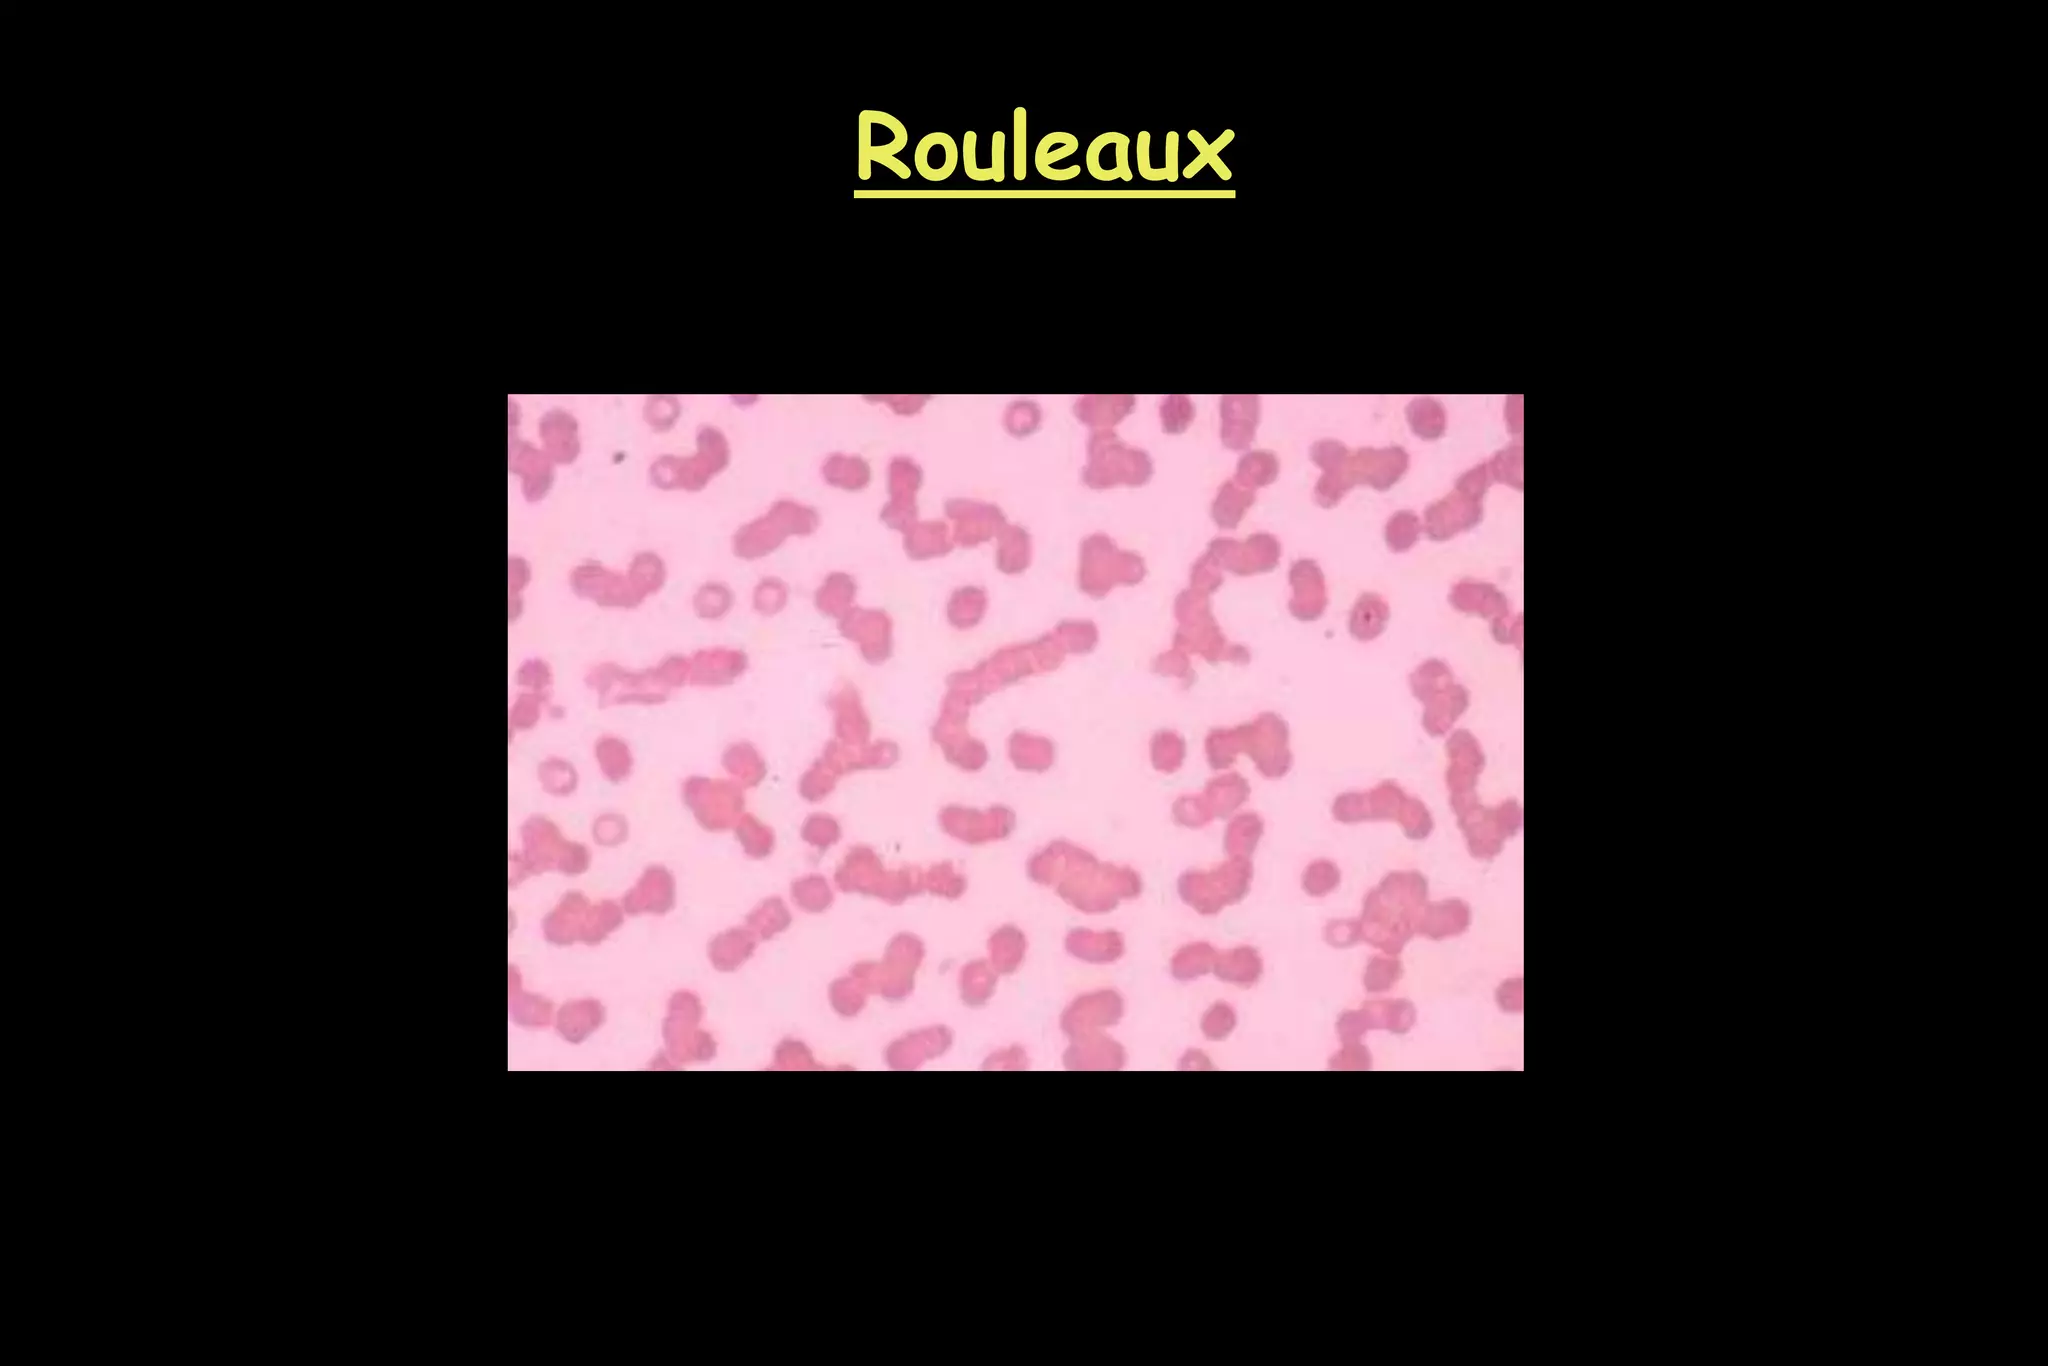
Rouleaux
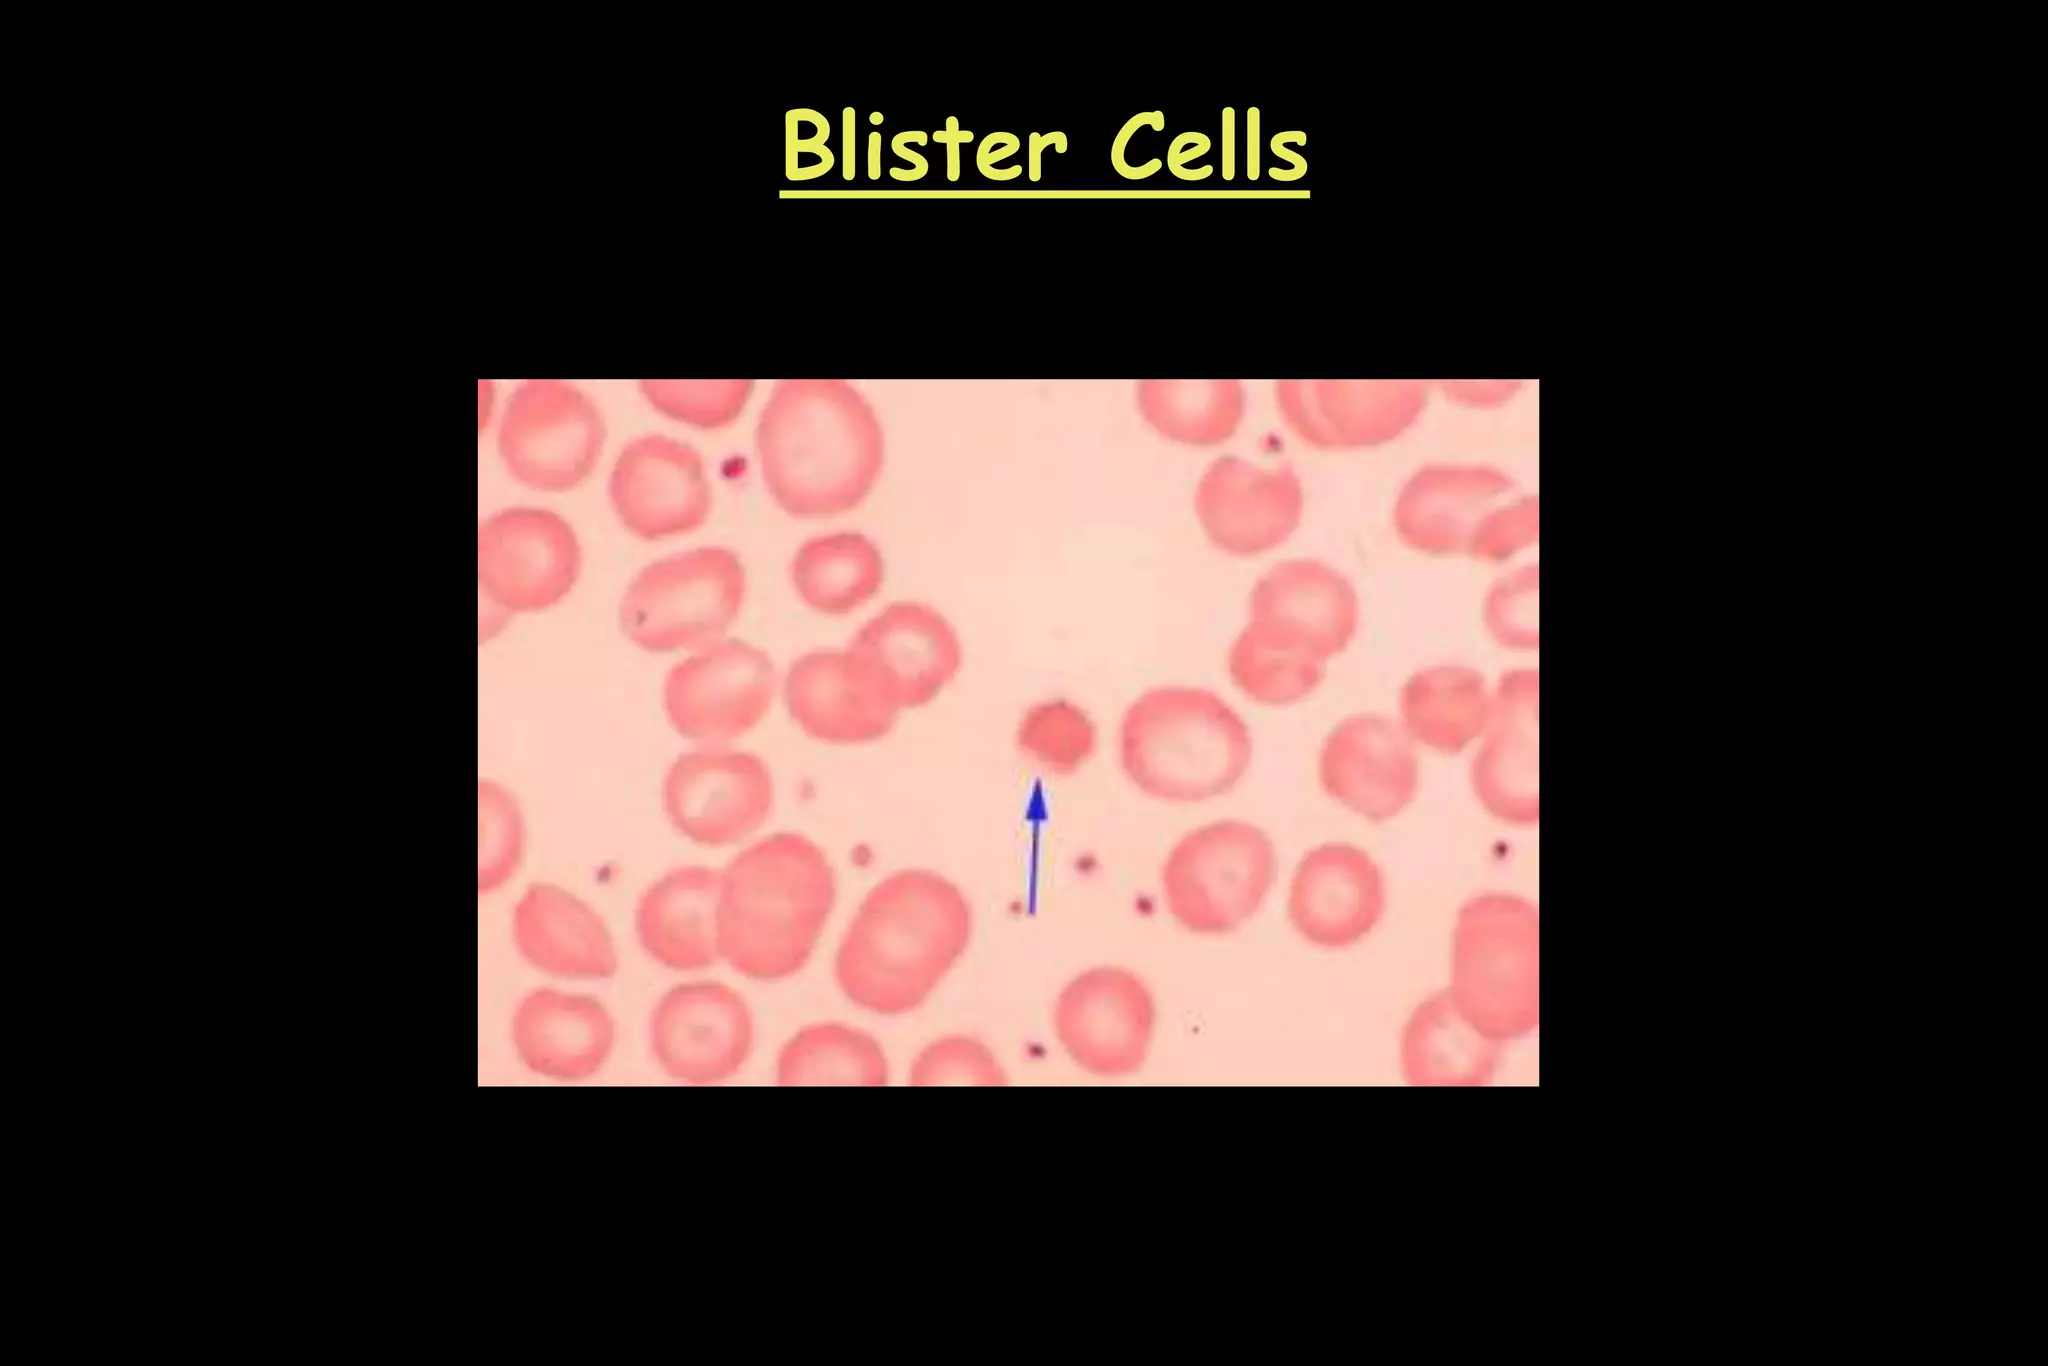
Blister Cells
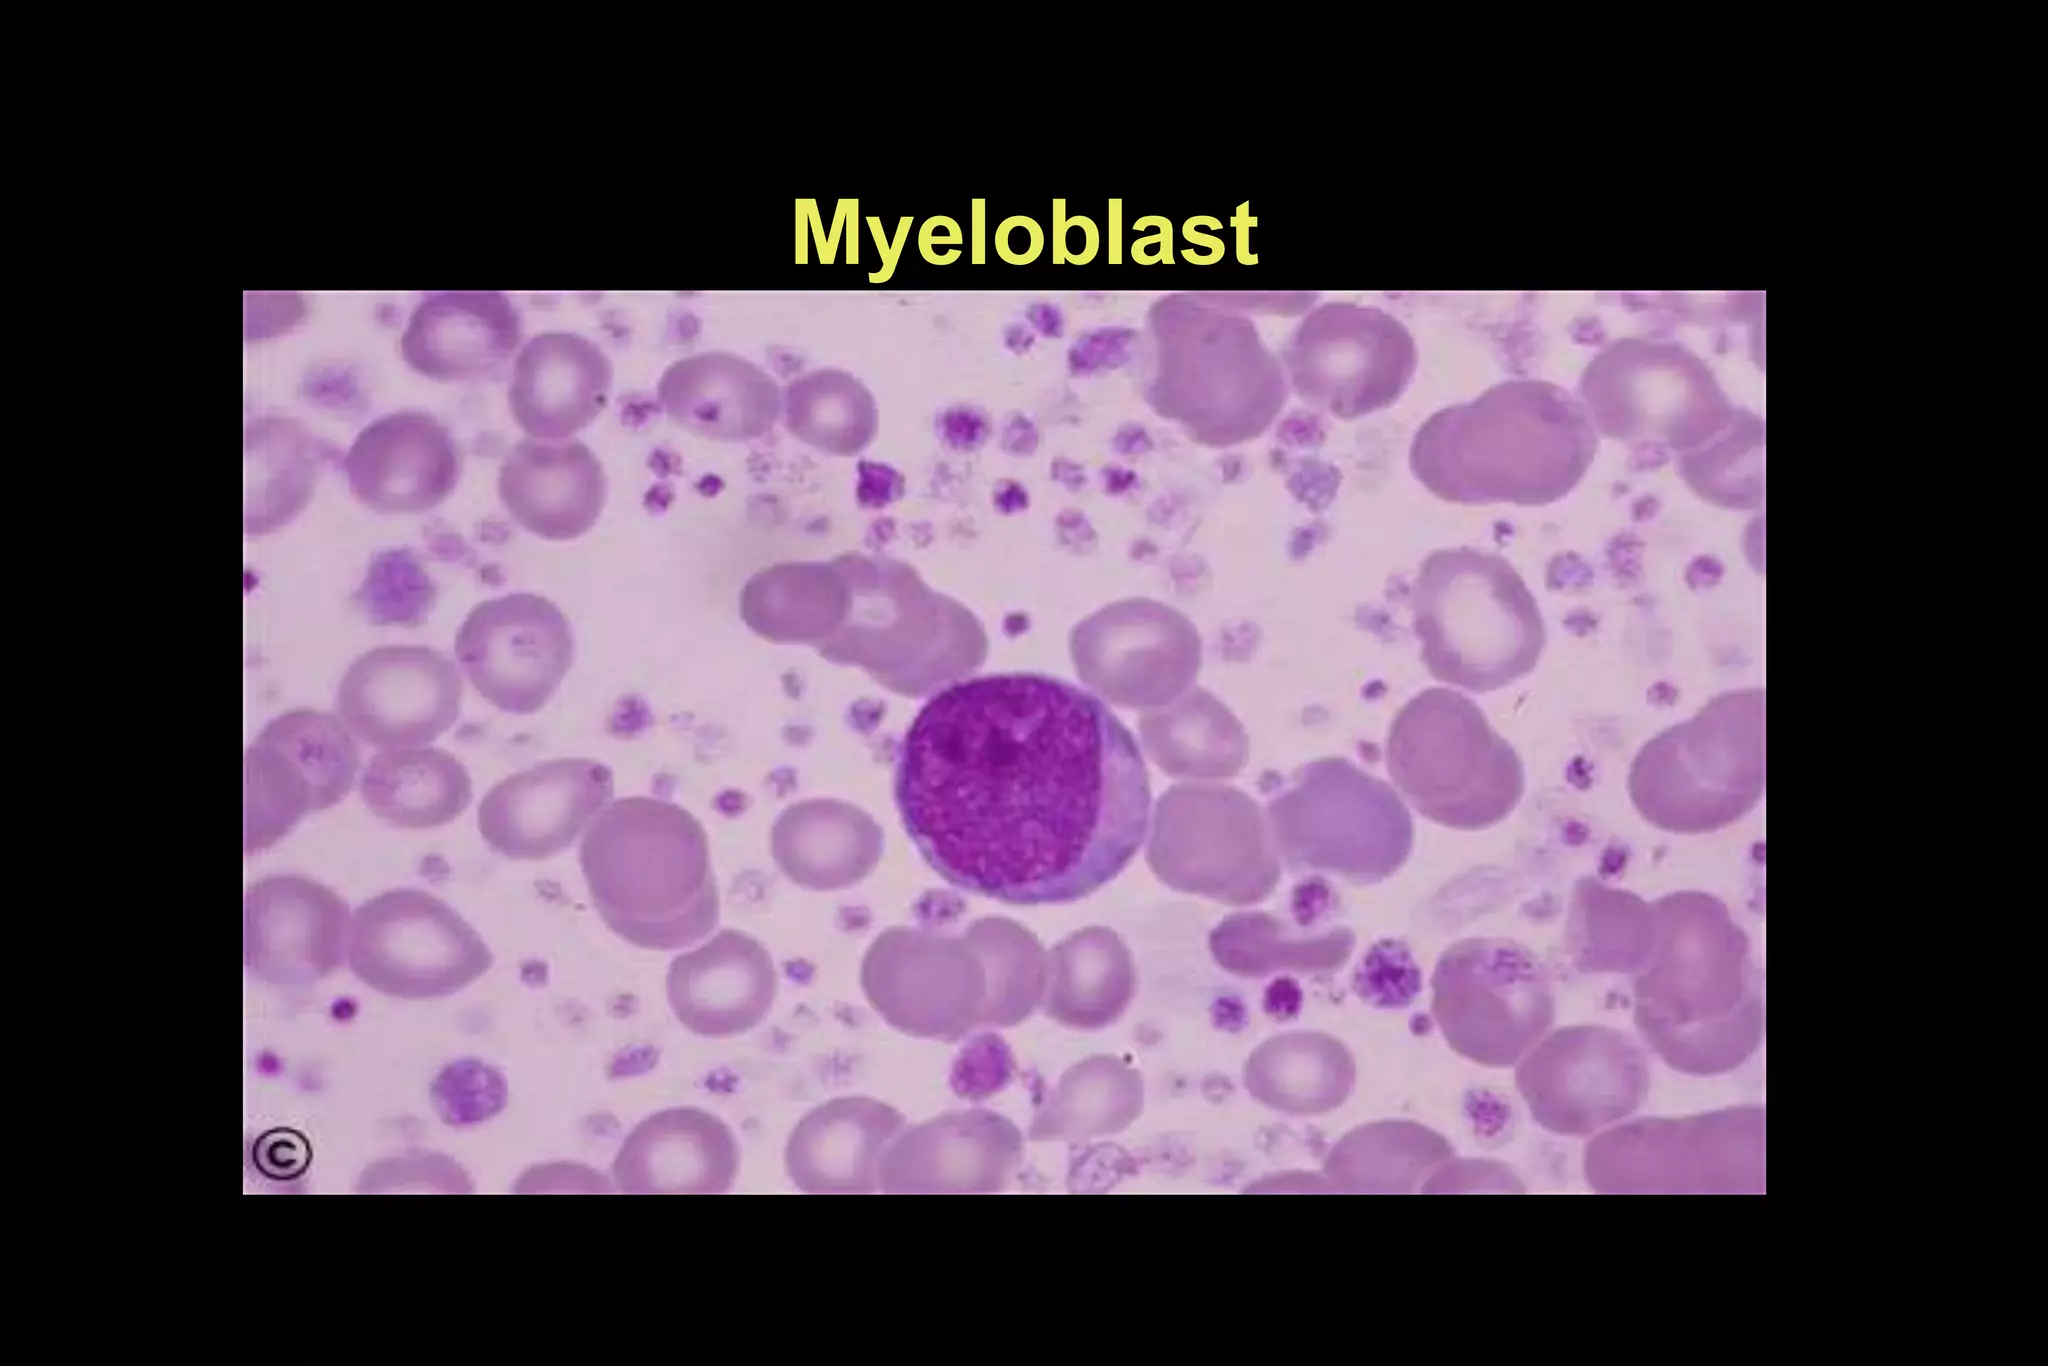
Myeloblast
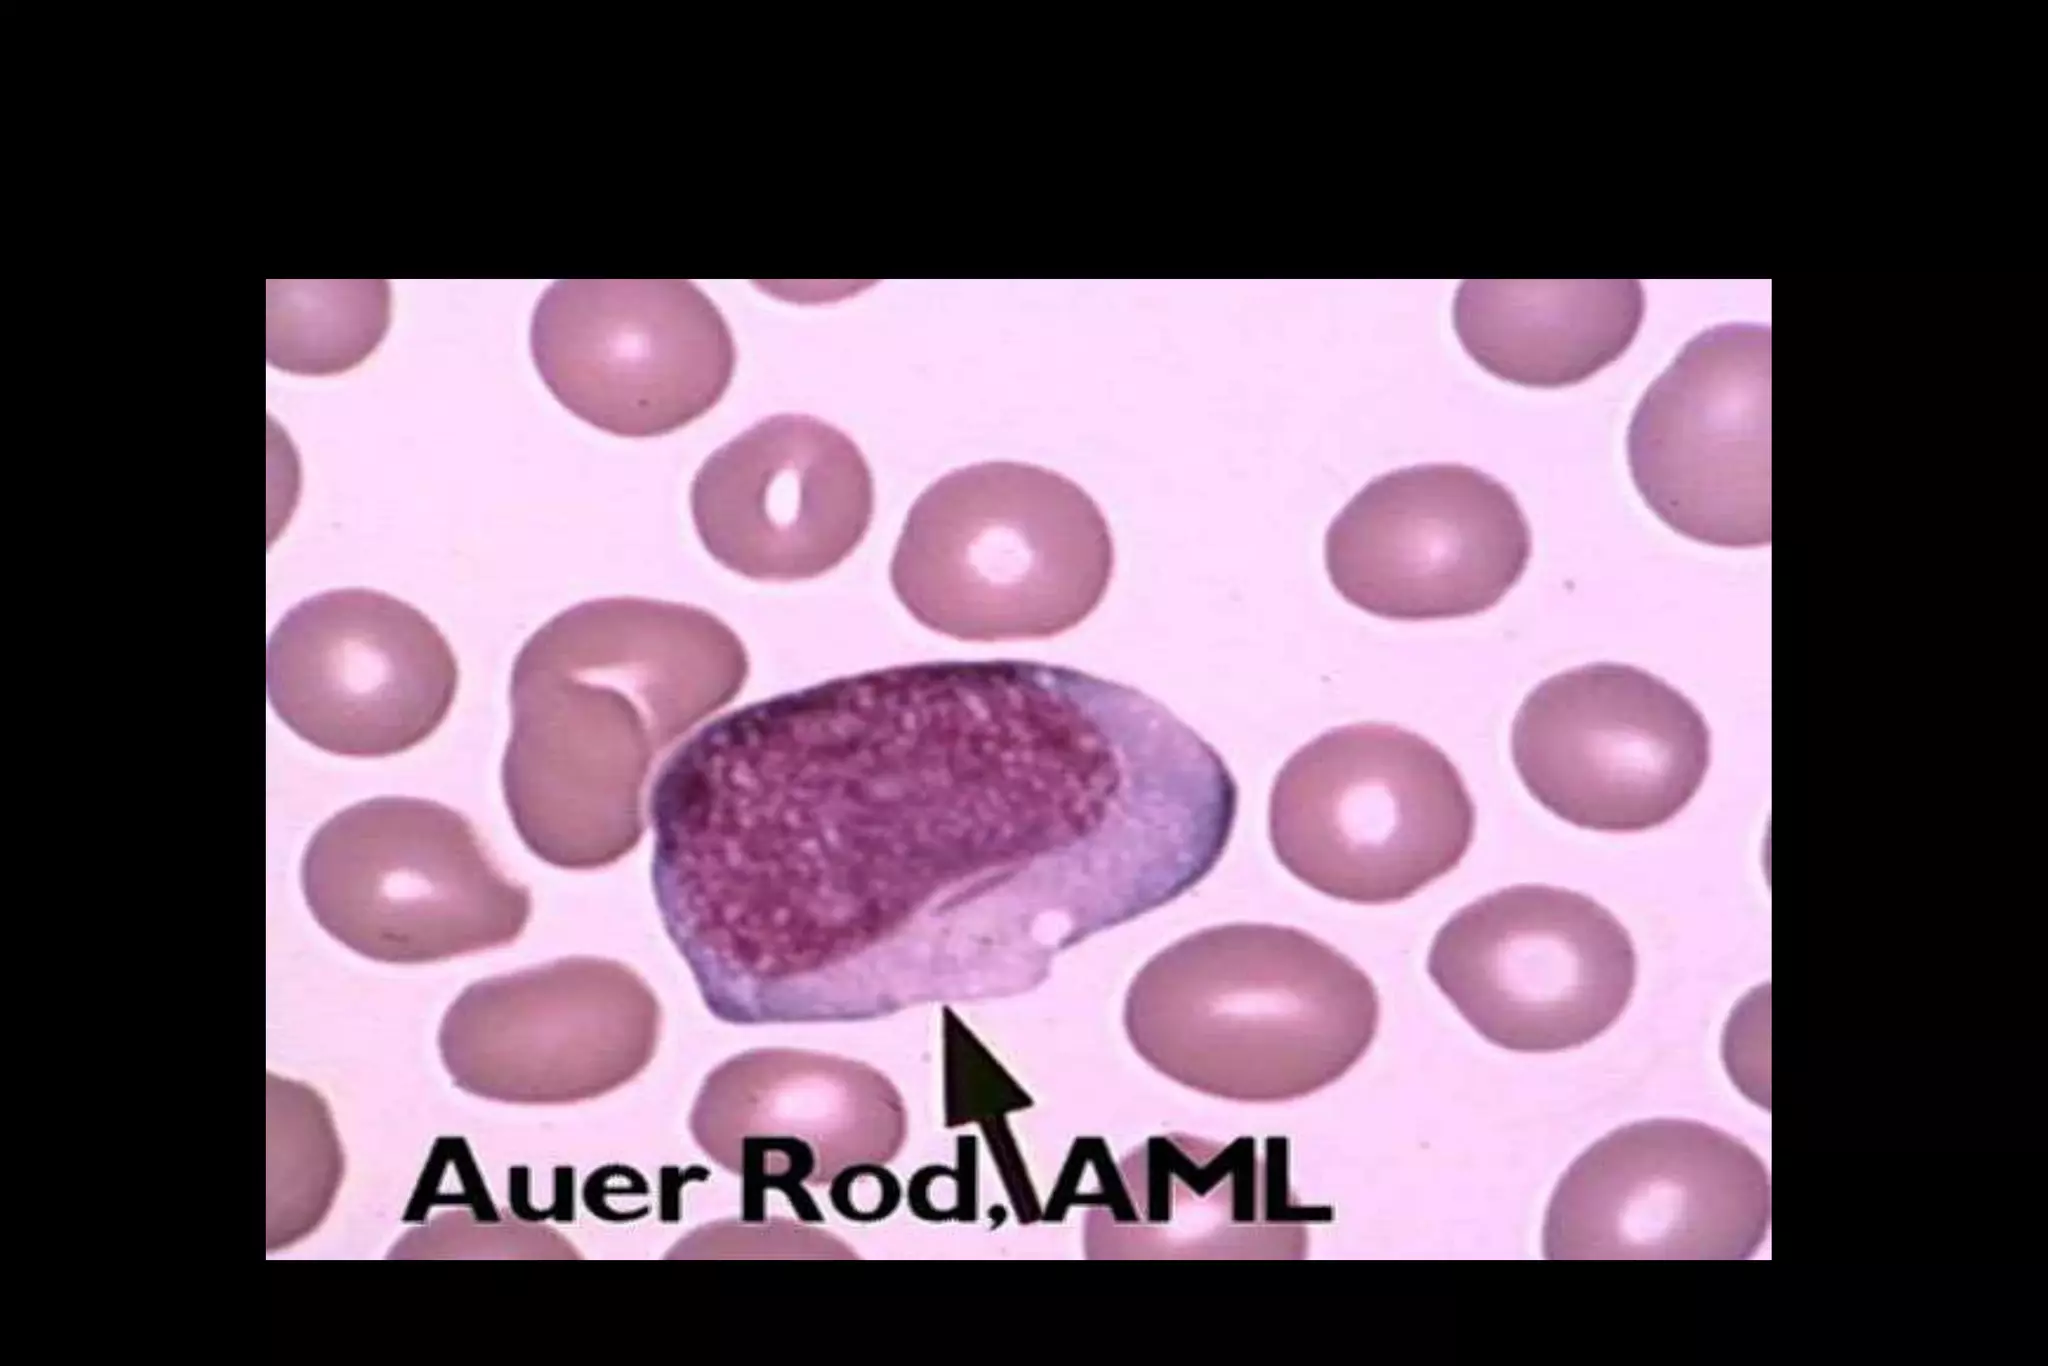
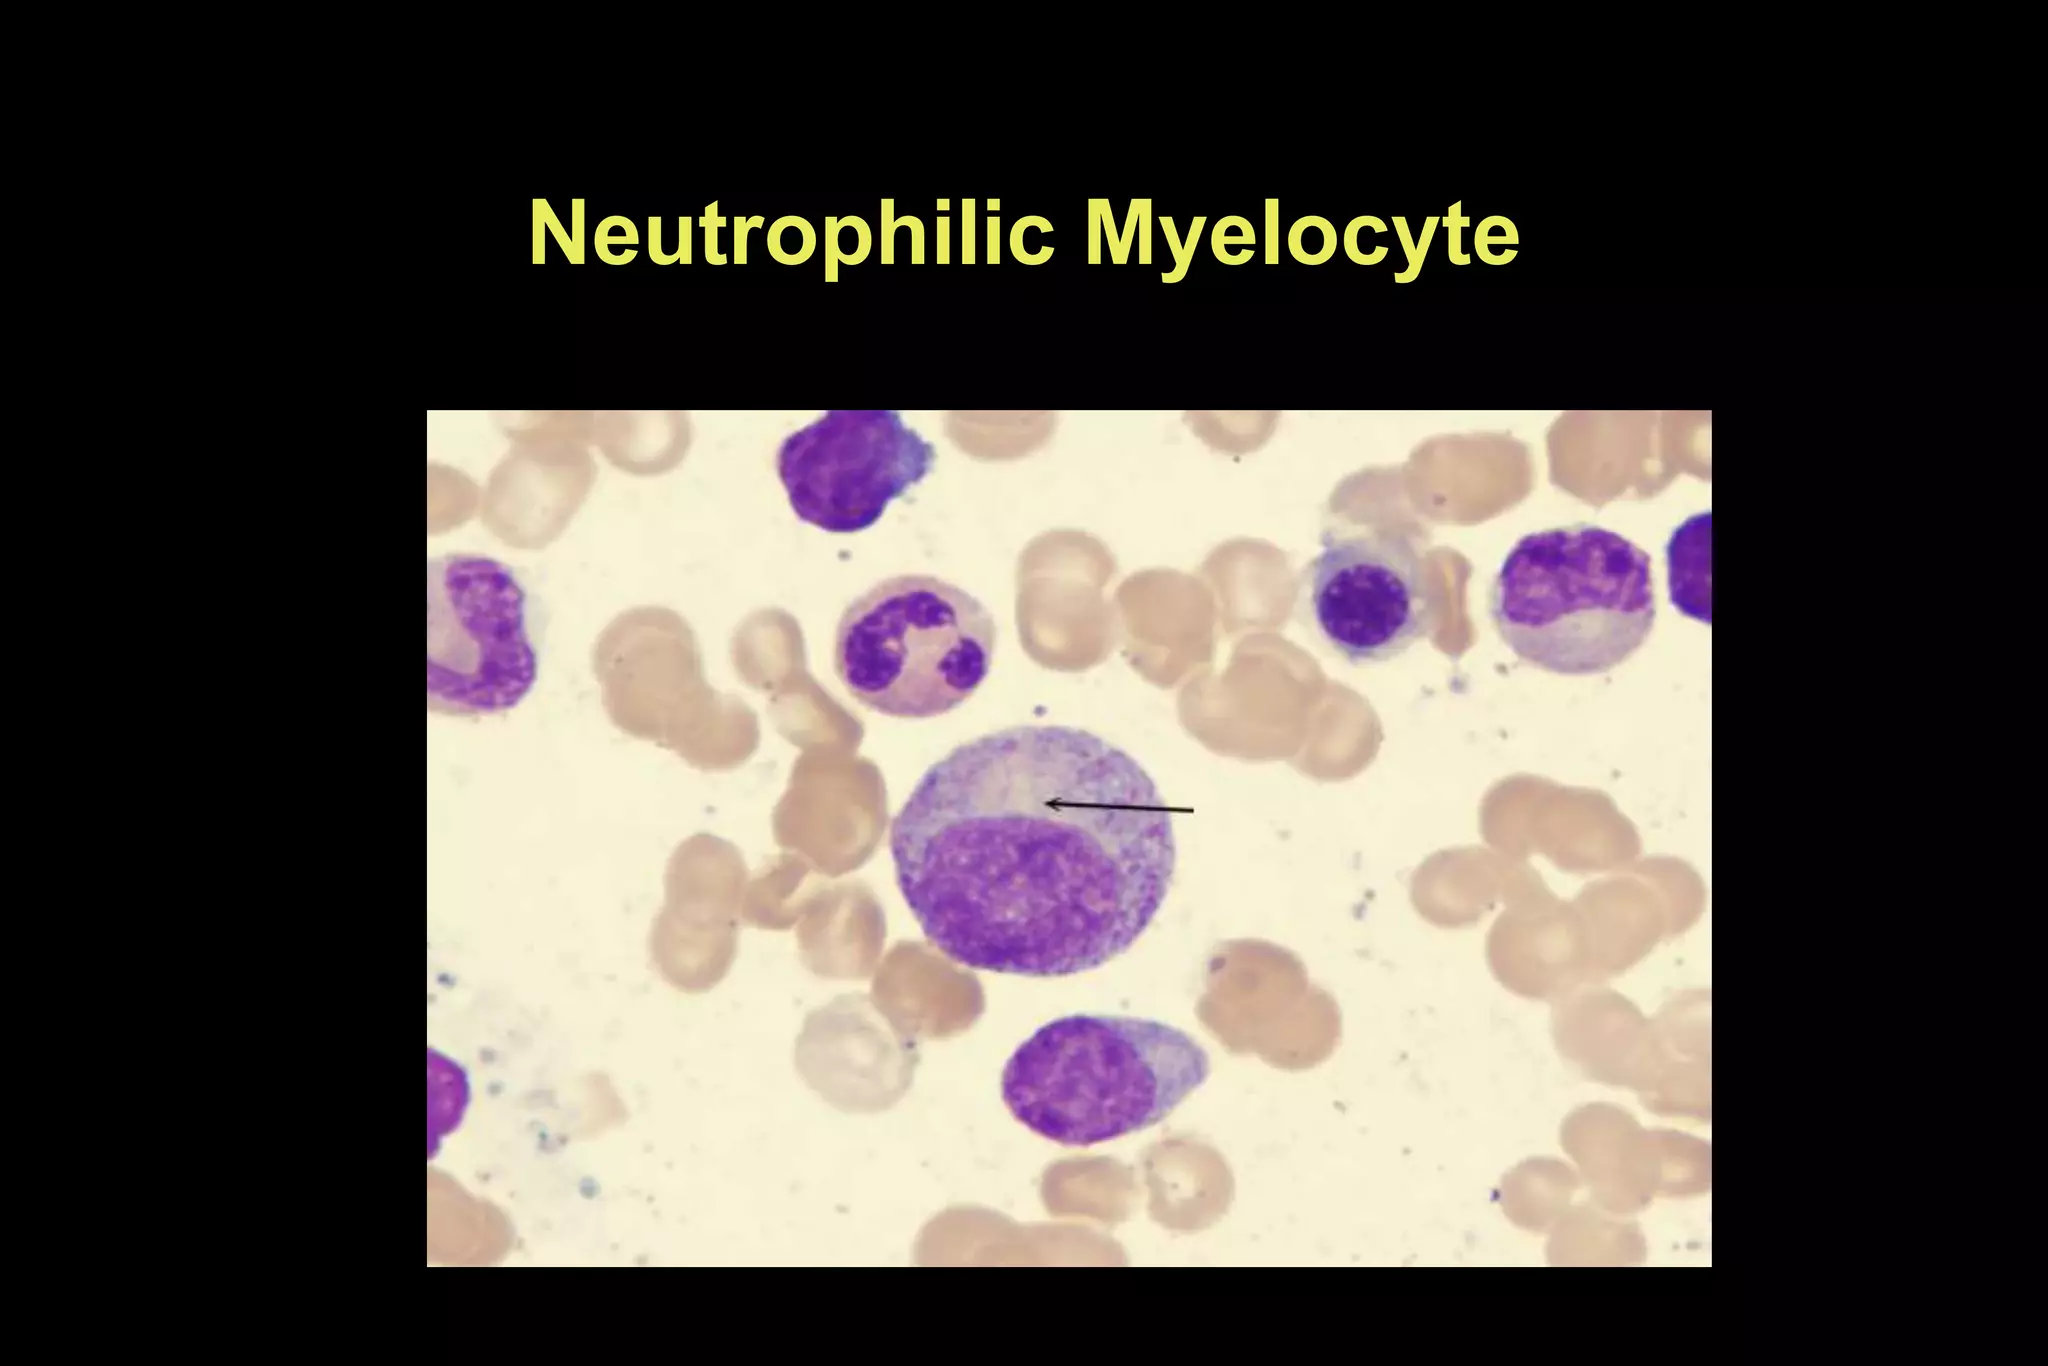
Neutrophilic Myelocyte
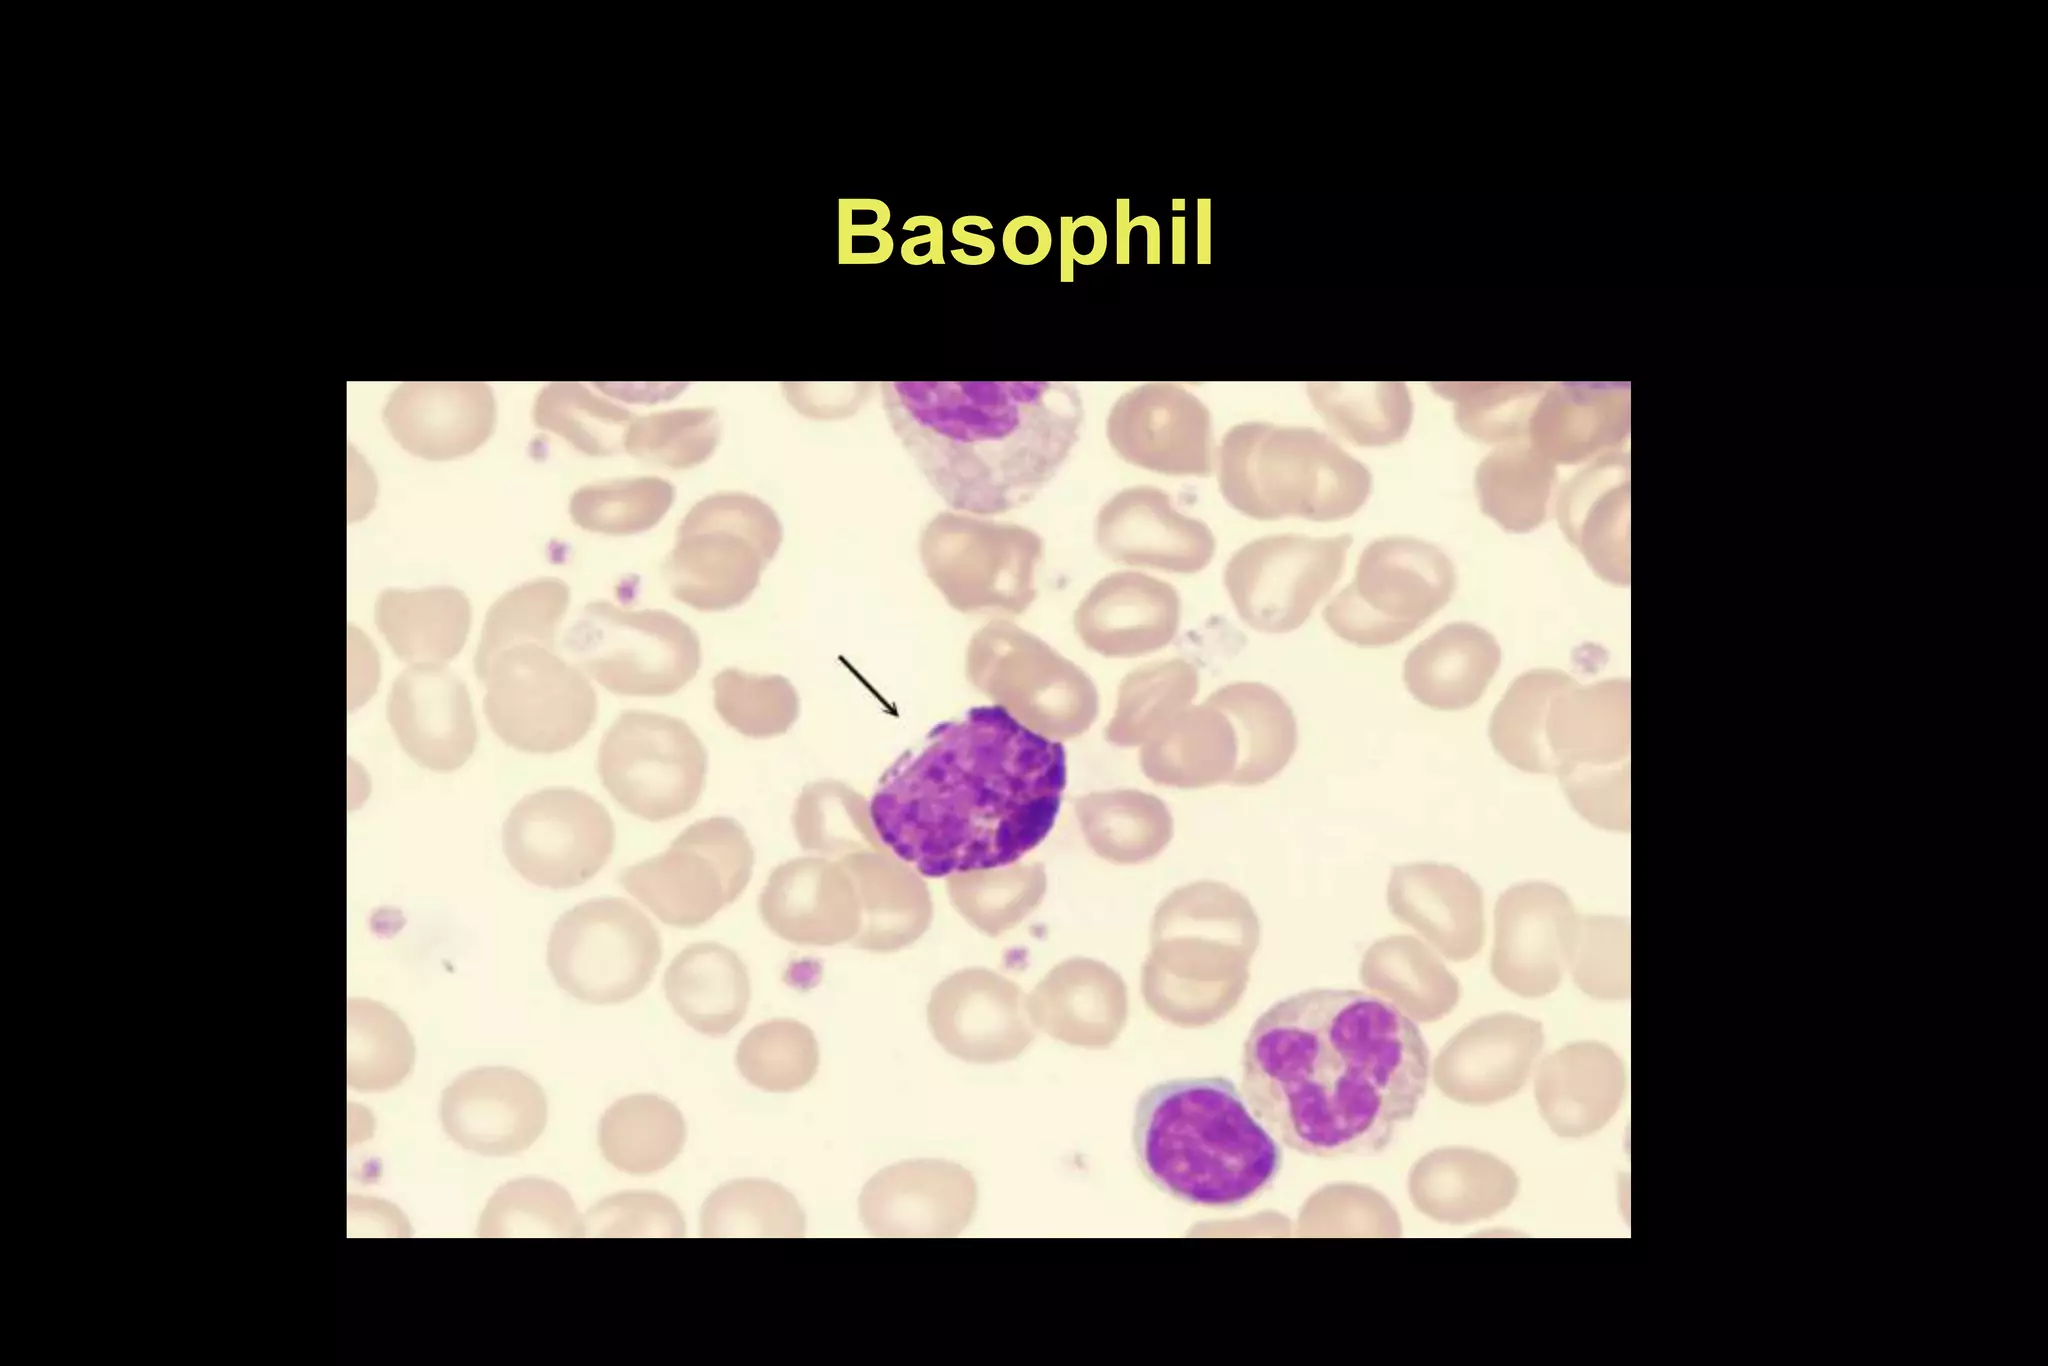
Basophil
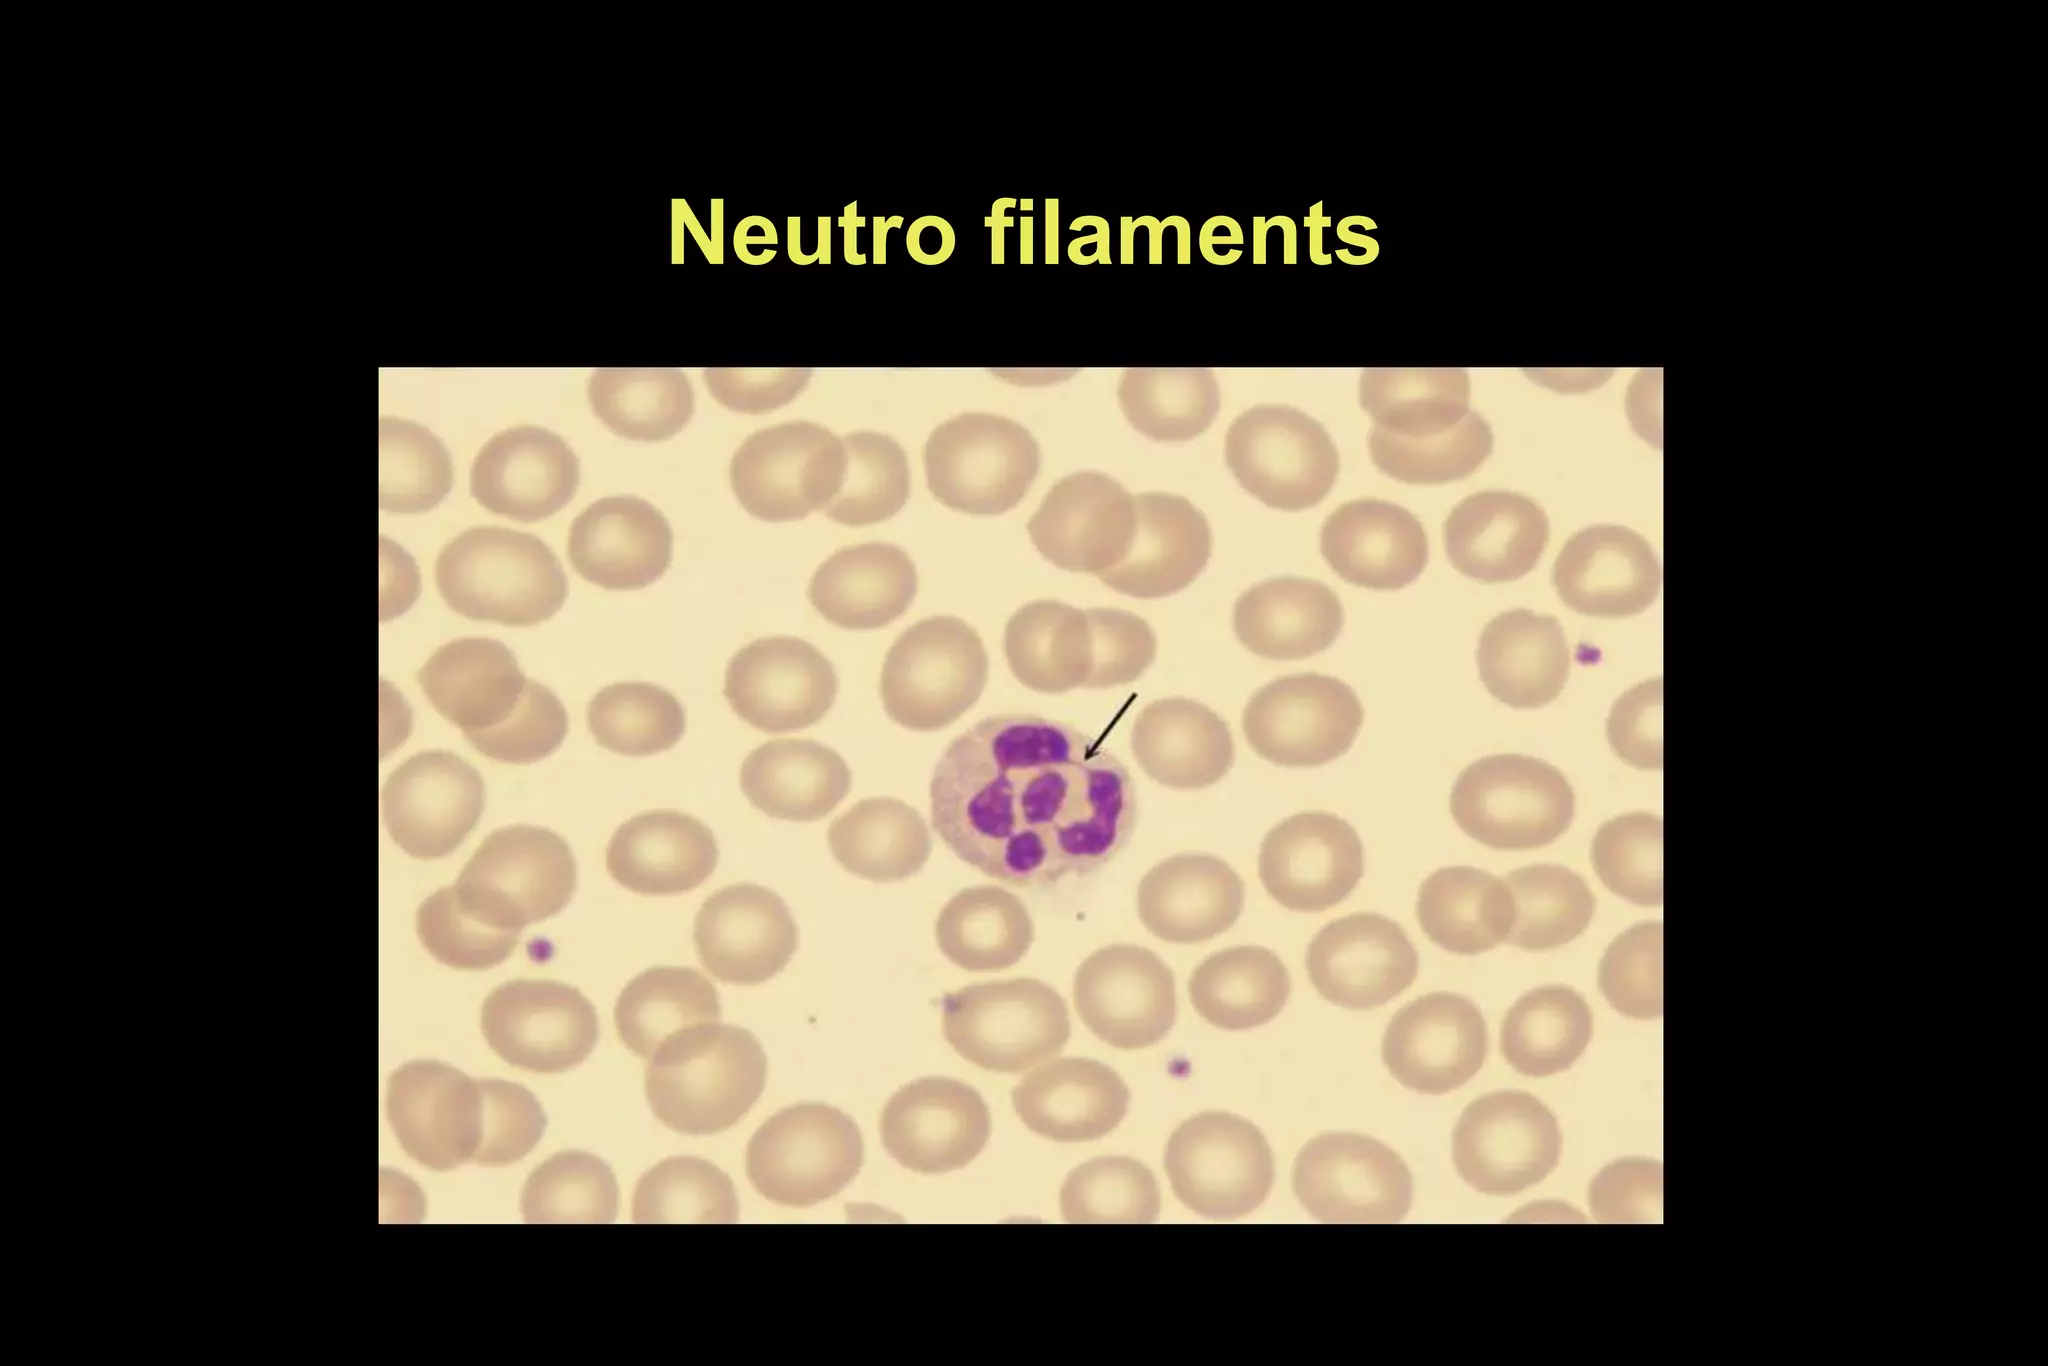
Neutro filaments
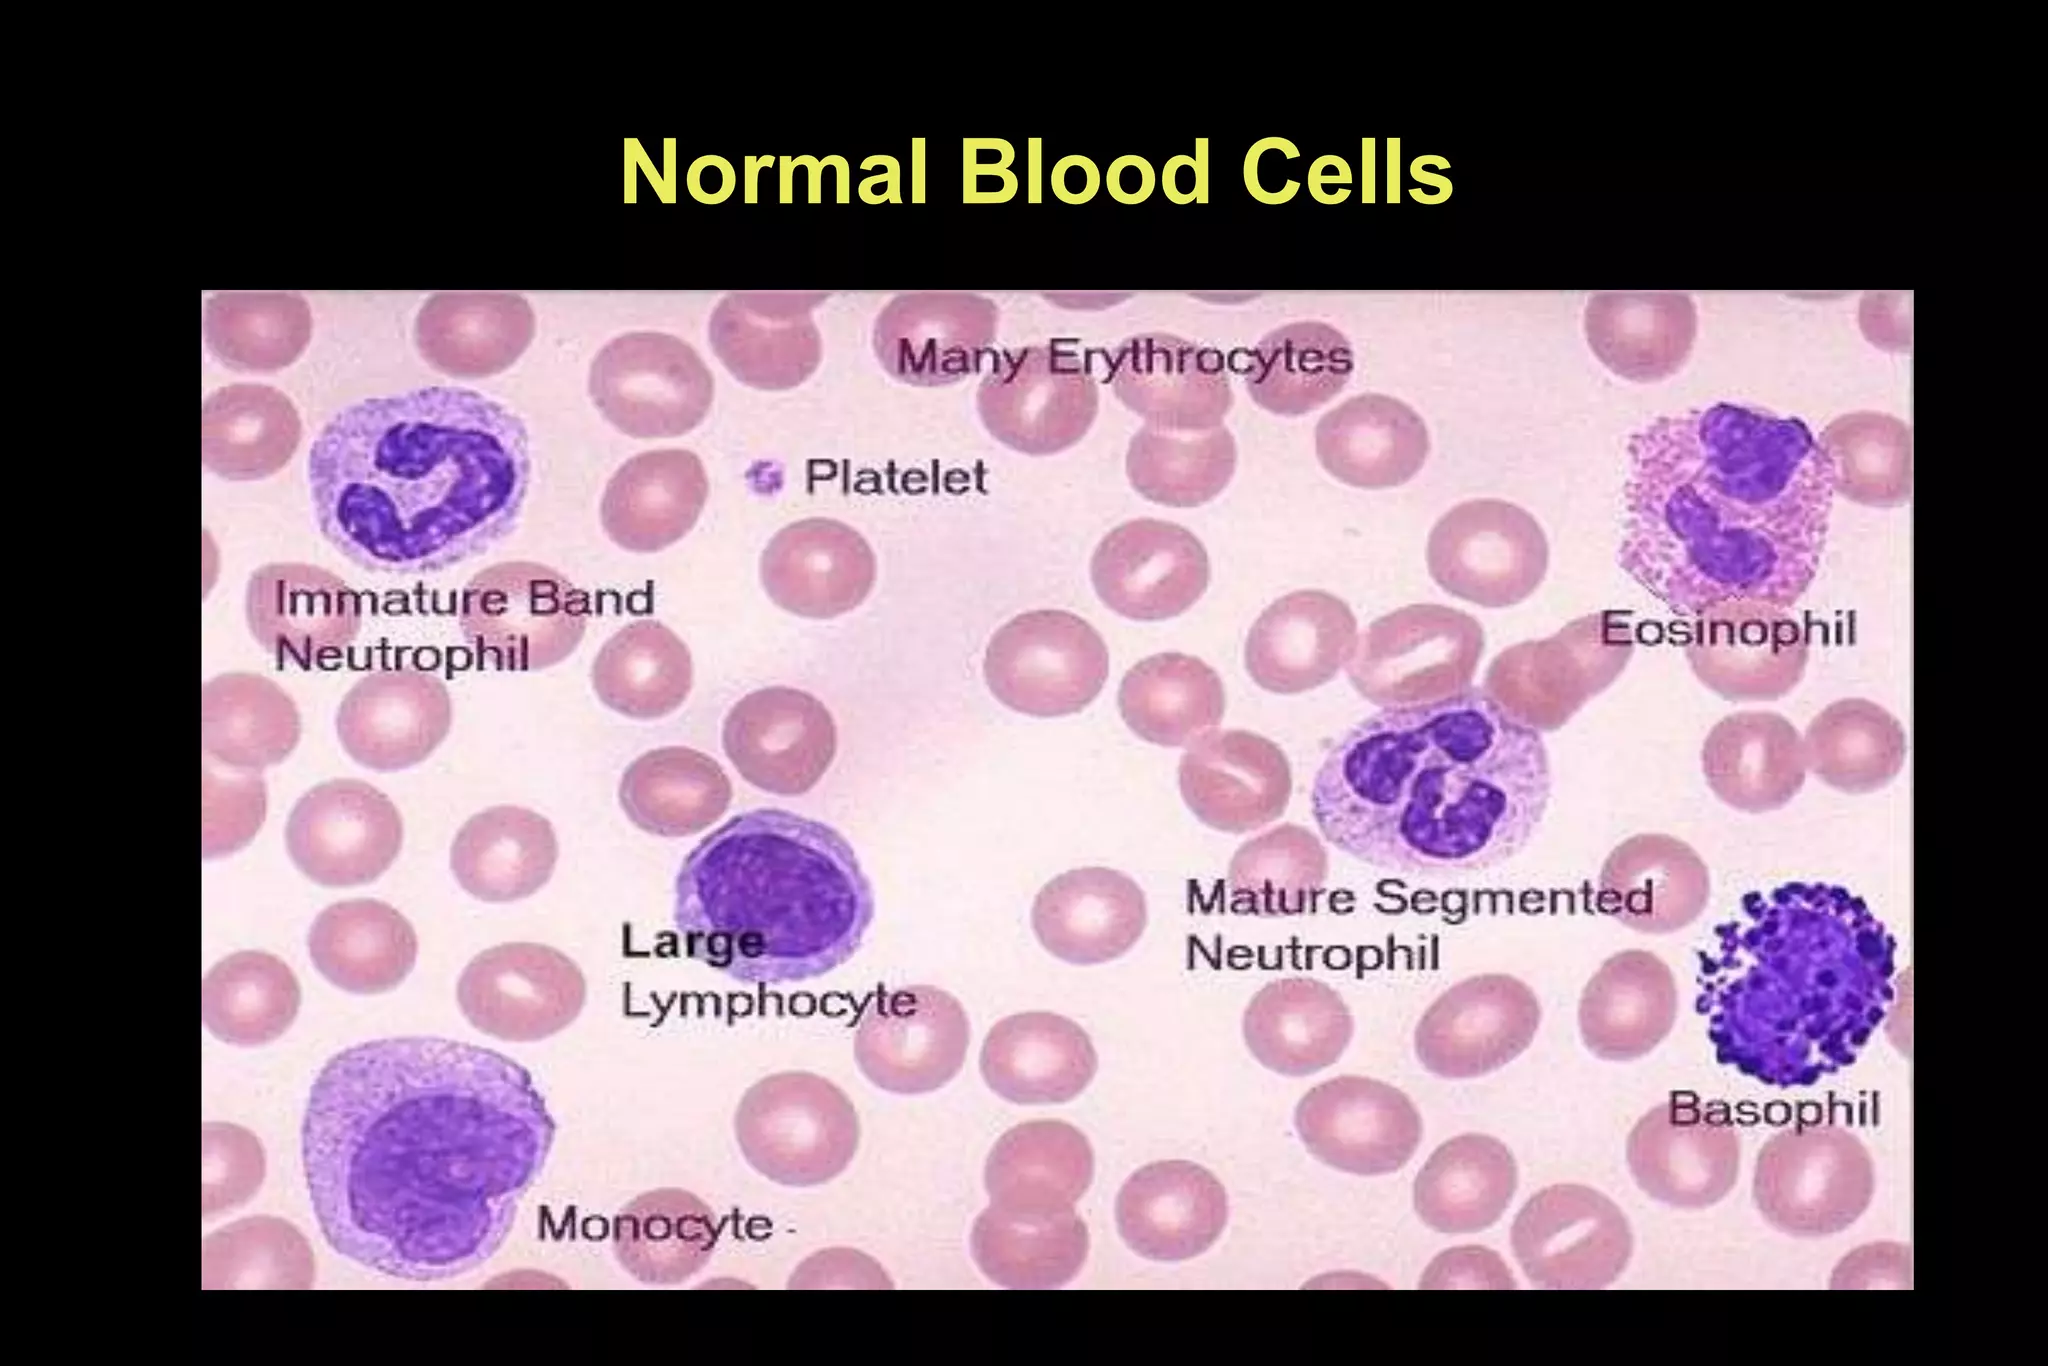
Normal Blood Cells
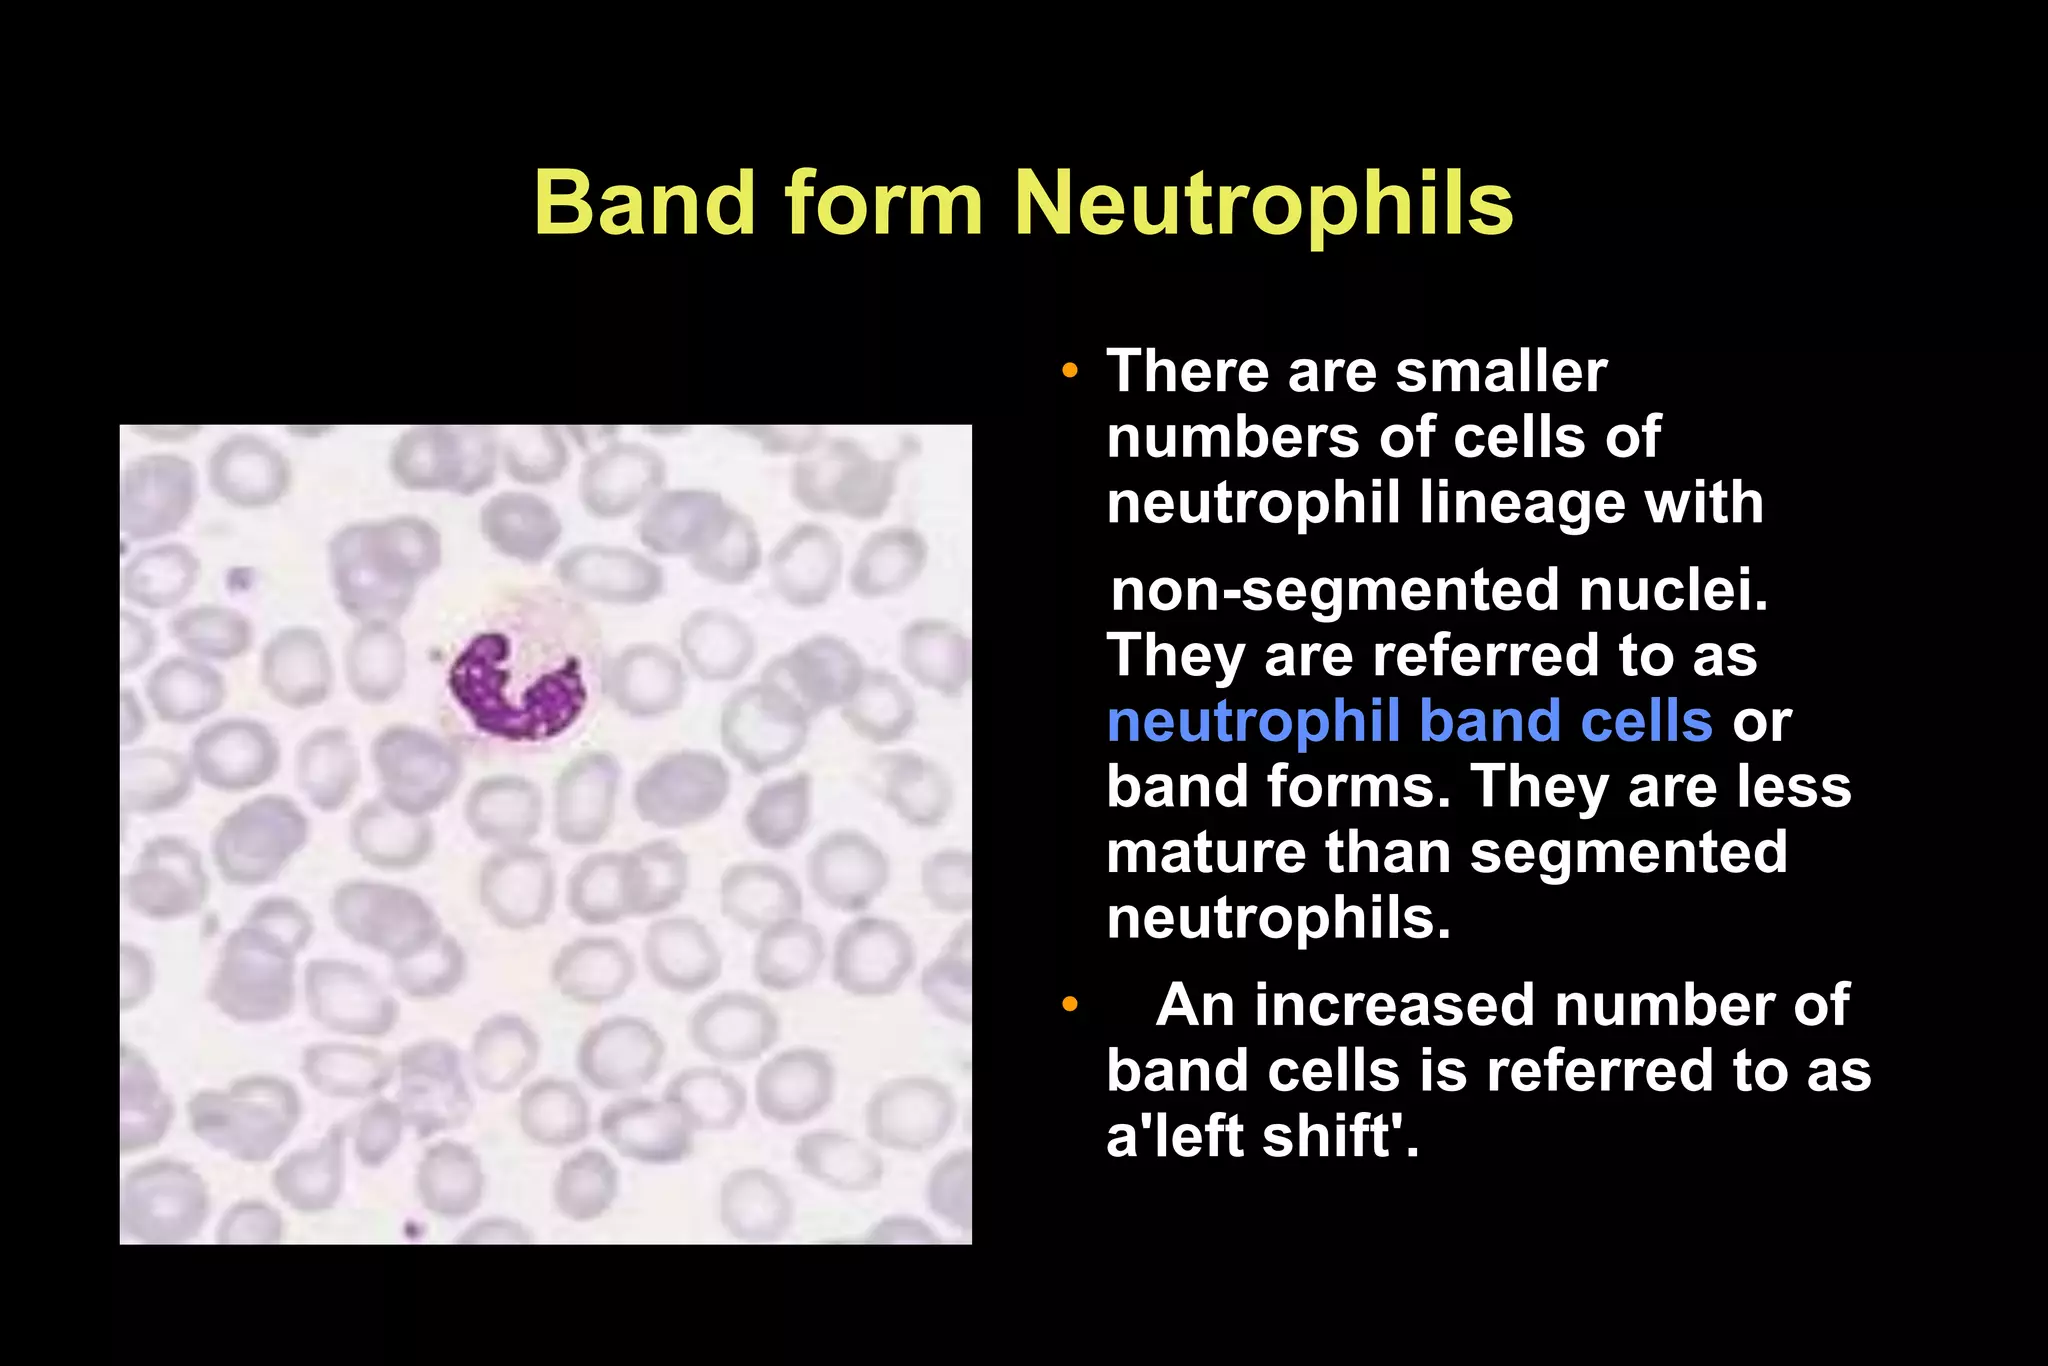
Band form Neutrophils
• There are smaller
numbers of cells of
neutrophil lineage with
non-segmented nuclei.
They are referred to as
neutrophil band cells or
band forms. They are less
mature than segmented
neutrophils.
• An increased number of
band cells is referred to as
a'left shift'.
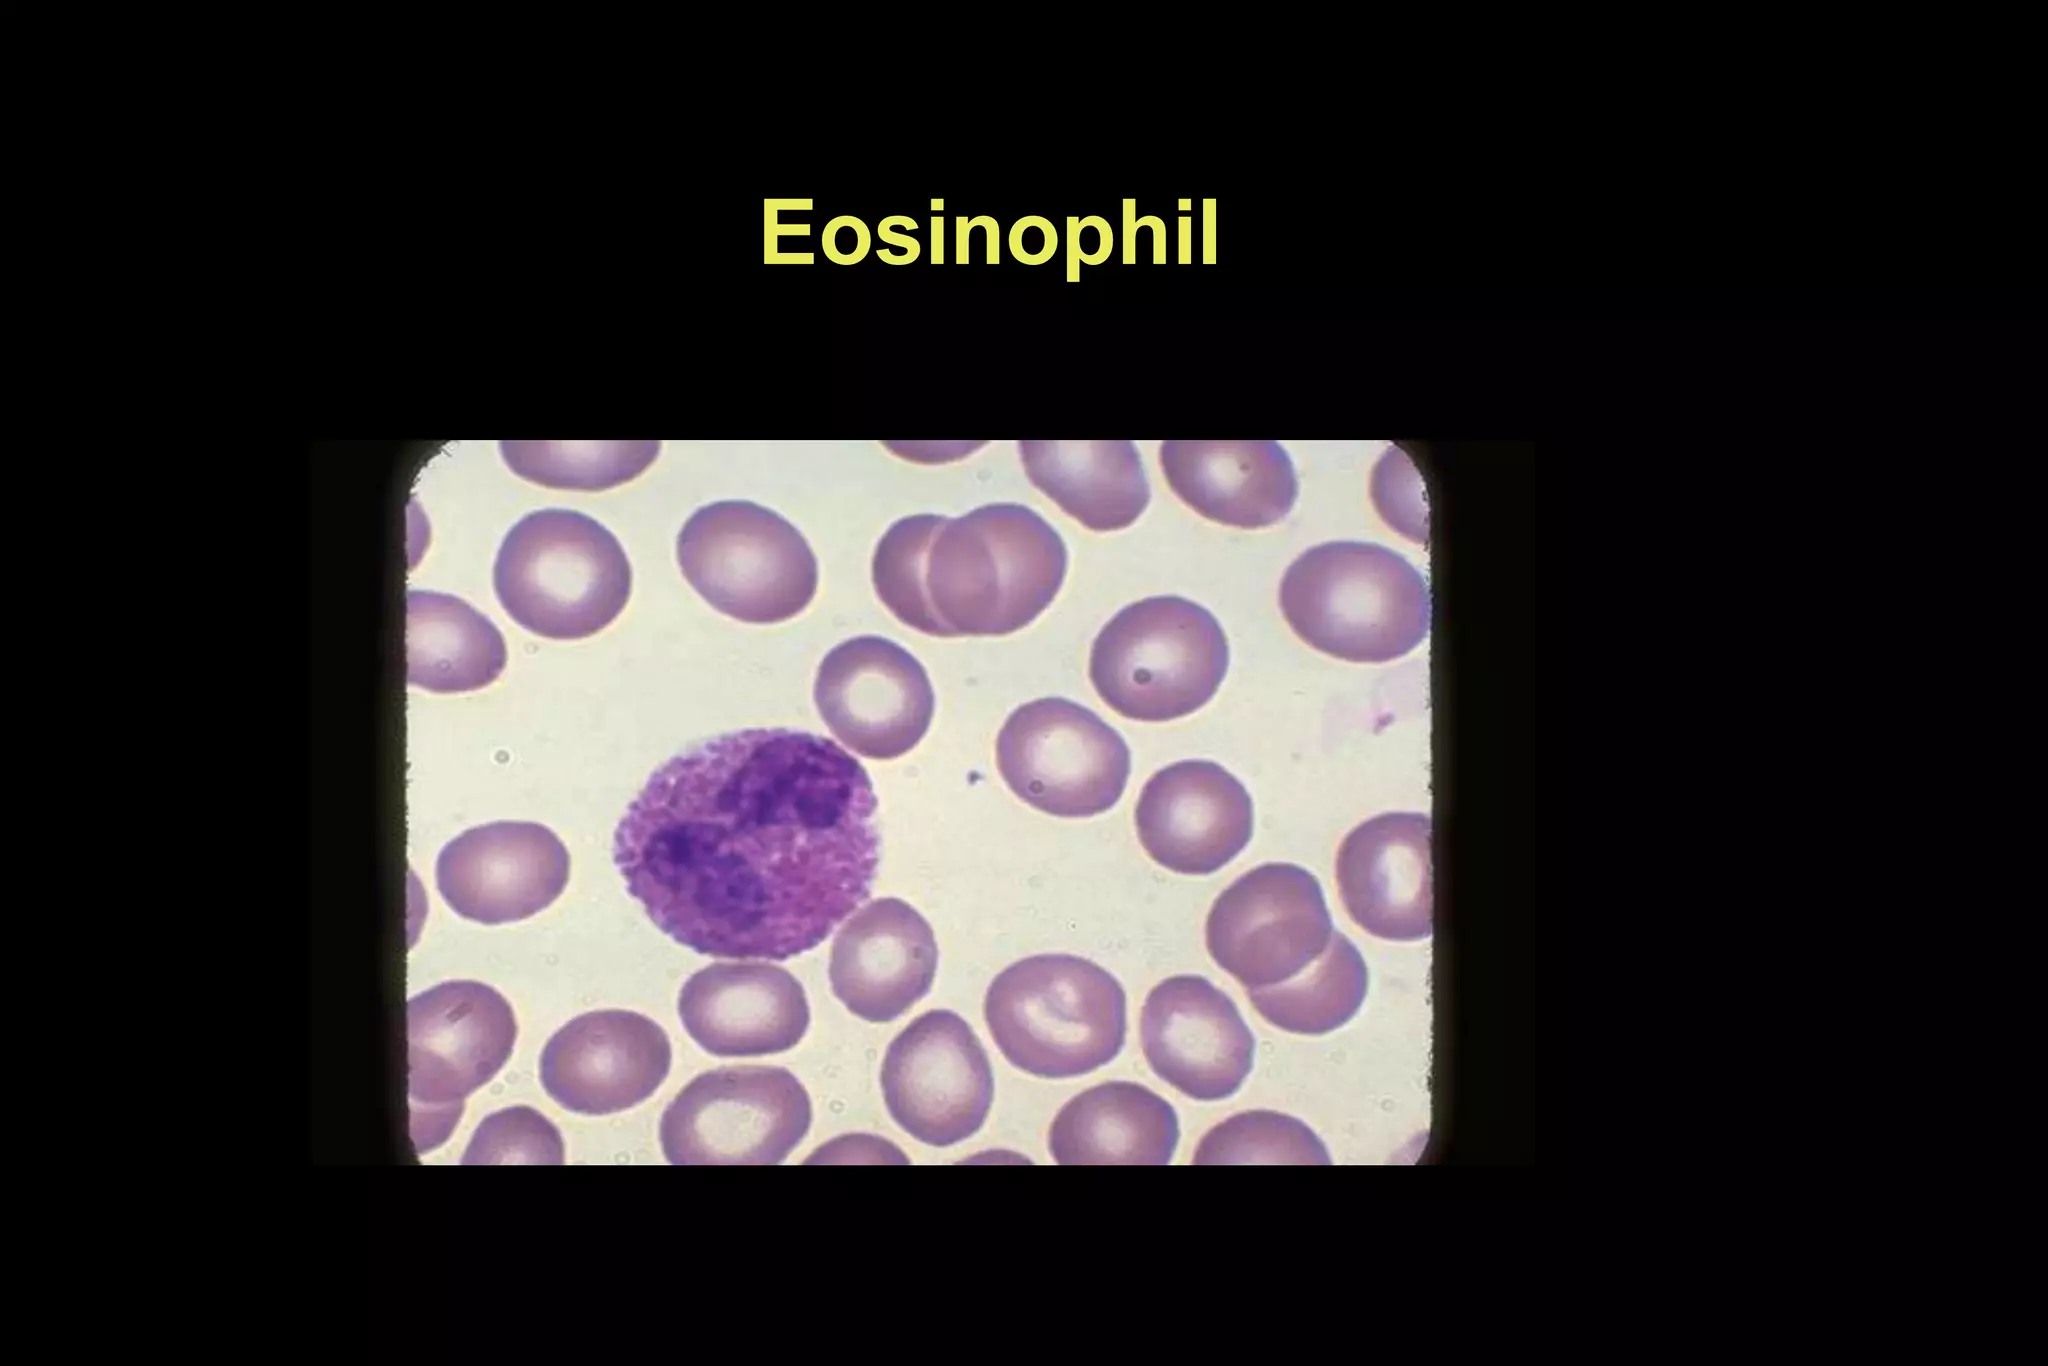
Eosinophil

This document describes various normal and abnormal red blood cell and white blood cell morphologies seen in blood cell examination. It discusses normal red blood cells and then various red blood cell abnormalities including hypochromic, poikilocytes, spherocytes, elliptocytes, target cells, and sickle cells. It also details the normal maturation process of granulocytes from myeloblast to neutrophil and the morphological characteristics of myeloblasts, promyelocytes, myelocytes, metamyelocytes, bands, and segmented neutrophils. Finally, it shows images and descriptions of normal lymphocytes, monocytes, eosinophils, basophils, and platelets.